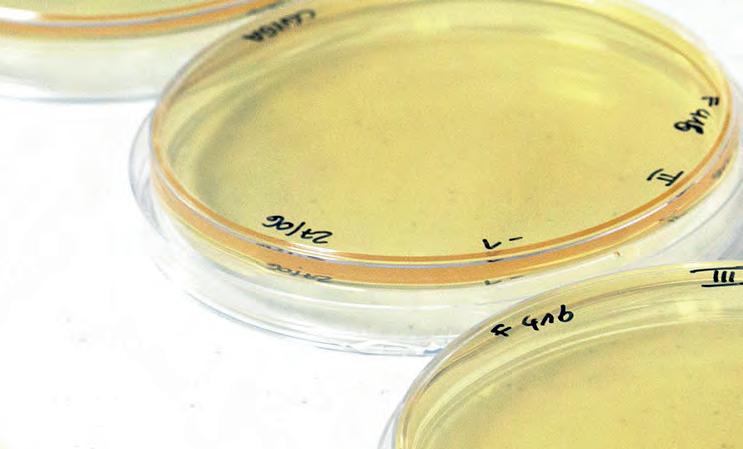
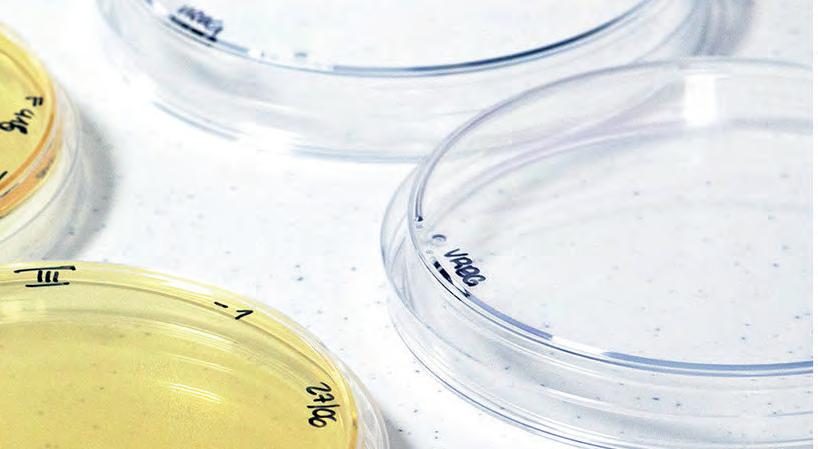

www.olioluglio.it www.pastacecchin.it










www.lecerque.com

www.moliniambrosio.com
www.tentazionipugliesi.it

www.tuttofood.it






![]()




www.olioluglio.it www.pastacecchin.it










www.lecerque.com

www.moliniambrosio.com
www.tentazionipugliesi.it

www.tuttofood.it







Risotti, pasta, zuppe, pizze, secondi, insalate. È facile cucinare con Edelblu.
04 – 08 Oct 2025



MEDI SRL:Tthe best of the sea, between innovation and tradition. pp. 10/12 anuga special
FRECCIANERA FRATELLI BERLUCCHIL: Elegance and identity in the heart of Franciacorta. pp. 36/39 wine special


WELL ALIMENTARE ITALIANA SRL: Masters of flavor serving families, foodservice, and industry. pp. 20/23
editorial management and registered office: Via Cesare Cantù, 16 20831 Seregno (MB) - ITALY Tel. +39 0362 244182
Catalogue of Food & Beverage products for retailers, buyers, and hospitality sector. Published: annual Registration: Court of Monza 15/2018 of 13.11.18


MANIVA SPA: 1864 meters ASL. pp. 90/92 water
e-mail: marketing@allfoodonline.com skypeTM: editricezeus stampa 3-25 - ANUGA In partnership with:
web site: www.editricezeus.com
e-mail: redazione@editricezeus.com portal: www.allfoodonline.com
Showcase of food&beverage products, wines and alcoholics year 11 - 2025

BERTOLO SRL: Tradition, innovation and quality. pp. 106/109




D’ORO SRL: When taste of tradition meets the future. pp. 118/121

Sonia V. Maffizzoni Editorial Manager
The food and beverage world is moving with a new rhythm. In foodservice, the table becomes a stage where flavour, wellness and sustainability meet.




S.V. Maffizzoni redazione@editricezeus.com

editorial production Sonia Bennati bennati@editricezeus.com
Wines tell stories of land and passion, carrying tradition into the future with innovative styles. Healthy food takes centre stage, with natural ingredients, clean labels and lighter recipes that speak to a global search for balance.
Quality is no longer just a standard: it is an experience made of authenticity, taste and care.
This issue reflects that journey, exploring how products and ideas are shaping a new culture of food and hospitality.
account dep. manager Elena Costanzo amministrazione@editricezeus.com
project and layout design creative dep. ZEUS Agency grafica@editricezeus.com translations Zeus agency printing Zeus agency
by Sonia bennati

Edited by SONIA V. MAFFIZZONI BENNATI
The food & beverage landscape continues to evolve, and Anuga, one of the most important global events for the sector, confirms its role as the place to anticipate the trends that will shape the market.
At the helm of the trade fair, Jan Philipp Hartmann, who shared with us his vision of the key themes that will guide the industry of tomorrow, ahead of Anuga 2025 in Cologne.
What are the main trends we will see at Anuga 2025?
We are witnessing a clear shift towards personalized nutrition. Consumers want to know what they are eating, they want to benefit from it, and to do so they need to make conscious dietary choices. Nutrition thus becomes a tool to improve quality of life.
And in terms of innovation?
Innovation has always been an integral part of Anuga, the largest food & beverage event in the world.
Exhibitors present their new products in special areas such as the Boulevard of Innovations, which brings together startups, or in the showcase dedicated to products introduced after 2023.
Yet, real innovation can be found in the halls, among the more than 8,000 exhibitors that make the fair unique.
Sustainability is no longer just a trend but a crucial theme in the industry. How does Anuga address it?
As you rightly said, Sonia, it is no longer just a trend, but a reality. Being sustainable is essential to ensure food availability both today and in the future.



by Jan Phillip Hartmann Director Anuga

Lo scenario del food & beverage continua a evolversi e Anuga, uno degli appuntamenti più importanti a livello mondiale per il settore, si conferma il luogo in cui leggere in anticipo le tendenze che segneranno il mercato.
Alla guida della manifestazione, Jan Philipp Hartmann, che ha condiviso con noi la sua visione sui temi chiave che orienteranno l’industria di domani, in vista di Anuga 2025 a Colonia.
Quali sono le principali tendenze che vedremo ad Anuga 2025?
Assistiamo a un chiaro sviluppo verso la nutrizione personalizzata. I consumatori vogliono sapere
cosa stanno mangiando, desiderano trarne benefici concreti e, per farlo, hanno bisogno di scelte alimentari consapevoli.
La nutrizione diventa così uno strumento per migliorare la qualità della vita.
E sul fronte dell’innovazione?
«L’innovazione è da sempre parte integrante di Anuga, il più grande evento al mondo dedicato al food & beverage.
Gli espositori presentano le loro novità in aree speciali come il Boulevard of Innovations, che riunisce le startup, o nella vetrina riservata ai prodotti introdotti dopo il 2023.
Ma la vera innovazione si trova nei padiglioni, tra gli oltre 8.000 espositori che rendono unica la fiera».

by Sonia bennati
This is what customers expect all over the world. That’s why it is fundamental for exhibitors and visitors to share experiences and solutions on how to produce more sustainably.
During the show, our stages will host a rich program dedicated to this topic, where companies’ concrete practices will be discussed.”
What numbers are you expecting for the upcoming edition?
The last edition of Anuga, in 2023, hosted almost 8,000 exhibitors from 120 countries and 140,000 visitors from more than 200 nations.
For 2025, we expect an even broader presence, with a degree of internationality that continues to be one of the fair’s strongest assets.
Anuga 2025 therefore promises to break new records, strengthening its role as a global platform for dialogue on nutrition, innovation and sustainability.
It will not only be a commercial showcase, but also a venue where the entire food & beverage supply chain can address the key challenges of the future: from the evolution of consumer habits towards healthier choices, to the need for innovations that combine quality and competitiveness, up to the shared responsibility of ensuring truly sustainable processes and products.
The Cologne trade fair thus reaffirms itself not only as a privileged observatory of new trends, but also as an essential meeting point for all those who want to shape the future of global nutrition.
www.anuga.com


La sostenibilità, oltre che ad essere un trend, è un tema ormai imprescindibile anche in questo settore. Come lo affronta Anuga?
Come hai già affermato tu, Sonia, non si tratta più solo di un trend, ma di una realtà.
Essere sostenibili è essenziale per garantire la disponibilità di cibo oggi e in futuro. È ciò che i clienti si aspettano in ogni parte del mondo. Per questo è fondamentale che espositori e visitatori condividano esperienze e soluzioni per produrre in modo più sostenibile.
Durante la manifestazione, i nostri palchi ospiteranno un ricco programma di contenuti dedicati a questo tema, dove si discuterà delle pratiche concrete adottate dalle aziende.
Che numeri vi attendete per la prossima edizione?
L’ultima edizione di Anuga, nel 2023, ha visto la partecipazione di quasi 8.000 espositori provenienti da 120 Paesi e 140.000 visitatori da oltre 200 nazioni. Per il 2025 ci aspettiamo una presenza ancora più ampia, con
un livello di internazionalità che si conferma tra i punti di forza della manifestazione.
Un appuntamento che promette quindi di superare ogni record, rafforzando il ruolo della manifestazione di piattaforma globale per il dialogo su nutrizione, innovazione e sostenibilità.
Anuga 2025 non sarà soltanto una vetrina commerciale, ma un luogo in cui l’intera filiera del food & beverage potrà confrontarsi sulle sfide decisive per il futuro, dall’evoluzione dei consumi verso scelte più salutari, al bisogno di innovazioni capaci di coniugare qualità e competitività, fino alla responsabilità comune di garantire processi e prodotti realmente sostenibili.
La fiera di Colonia si conferma, dunque, non solo come osservatorio privilegiato delle nuove tendenze, ma anche come punto di incontro irrinunciabile per chi vuole costruire il futuro dell’alimentazione globale.
www.anuga.com

For over twenty years, we have been bringing premium seafood to Italian tables, blending tradition with innovation. With over 50 referencs divided into four product lines, Medi meets the needs of every consumer offering quality and variety.
Ondaviva represents the essence of the sea, with products categorized into four selections: Naturali, pure fillets and steaks; Misti, perfect for risottos and soups; Sughi, ideal for flavorful first courses; and Souté, designed for those who seek taste and convenience in just a few minutes. Invito is the line for those who seek the highest quality. Gourmet dishes transform every meal into a refined experience, while the Premium range offers classic, simple and quick solutions. Lastly, La Padellata combines convenience with authentic flavors in balanced dishes, ideal for any occasion.
Menù di Pesce is synonymous with versatility: appetizers, first courses, and main dishes that bring out the best flavors of the sea, adapting to any menu or dining occasion.
Mangiami con gusto is the perfect line for those looking for practical and reliable solutions every day. Highlights include Misto Scoglio, the rich Mare e Monti, the flavorful Spaghettata di Mare, the versatile Gamberi Sgusciati, and much more.
Medi’s quality is ensured by rigorous controls along the entire supply chain, with high-level international certifications such as: HACCP, BRC, IFS, ASC, and MSC. As an additional guarantee of food safety and reliability, all products carry the “Qualità Certificata Medi” seal.

MEDI: IL MEGLIO DEL MARE
TRA INNOVAZIONE E TRADIZIONE

Da oltre vent’anni portiamo sulle tavole italiane prodotti ittici d’eccellenza unendo tradizione e innovazione. Con oltre 50 referenze suddivise in quattro linee, Medi risponde alle esigenze di ogni consumatore, offrendo qualità e varietà.
Ondaviva è l’essenza del mare, con prodotti declinati in quattro categorie: i Naturali, filetti e tranci puri; i Misti, perfetti per risotti e zuppe; i Sughi, ideali per primi piatti ricchi di sapore; e i Souté, pensati per chi desidera gusto e praticità in pochi minuti.
Invito è la linea per chi cerca il massimo della qualità. I piatti Gourmet trasformano ogni pasto in un’esperienza raffinata, mentre la gamma Premium offre soluzioni classiche, semplici e veloci da preparare. Infine, La Padellata combina praticità e sapori autentici in piatti bilanciati, perfetti per ogni occasione.
Menù di Pesce è sinonimo di versatilità: antipasti, primi e secondi in grado di esaltare al meglio il sapore del mare, adattandosi a ogni tipo di menù e occasione.
Mangiami con gusto è la linea pensata per chi cerca soluzioni pratiche e affidabili ogni giorno. Tra le proposte di punta troviamo il Misto Scoglio, il ricco Mare e Monti, la gustosa Spaghettata di Mare, i versatili Gamberi Sgusciati e molto altro ancora.
La qualità Medi è garantita da rigorosi controlli lungo l’intera filiera, con certificazioni internazionali di alto livello: HACCP, BRC, IFS, ASC e MSC. A ulteriore garanzia di sicurezza alimentare e affi-
bev food&


Beyond its own branded products, Medi offers a highly competitive private-label service, thanks to its large-scale and flexible production capacity. As an ideal partner for GDO and DO, the company develops customized solutions tailored to any requirement.
With Medi, the quality of the sea is always within reach, ready to be transformed into an authentic and sustainable taste experience.
www.medisurg.it
dabilità, tutti i prodotti sono contrassegnati dal marchio “Qualità Certificata Medi”.
Oltre alla produzione a marchio proprio, Medi offre un servizio conto terzi altamente competitivo, grazie a una capacità produttiva flessibile e su larga scala.
Partner ideale per GDO e DO, l’azienda sviluppa soluzioni personalizzate adattabili a ogni esigenza.
Con Medi, la qualità del mare è sempre a portata di mano, pronta a trasformarsi in un’esperienza di gusto autentica e sostenibile.
www.medisurg.it






























Short supply chains are evolving through digital tools, connecting local producers directly with restaurants and retailers while preserving freshness, transparency, and sustainability. A smart blend of tradition and innovation.
In recent years, the concept of short supply chains has taken on new forms, far removed from the romantic image of the farmer bringing products directly to the market. Today, short supply chains are increasingly digital, supported by online platforms, dedicated marketplaces, and shared logistics systems that allow local producers to reach restaurants, farm stays, hotels, and even large-scale distribution with unprecedented ease.
What remains unchanged is the principle: reducing the distance between those who produce and those who consume, ensuring freshness, transparency, and sustainability.
Many farms, thanks to digital tools, can now offer their fresh products in real time to professional buyers, al-

by Walter Konrad
lowing for more efficient planning and reducing waste and middlemen.
For restaurateurs and hospitality operators, having direct access to these platforms means relying on dependable supplies, choosing seasonal products, and


diversifying their menus with ingredients that retain a direct link to the land. Technology thus serves tradition, making large-scale what was once limited to local and niche realities.
The advantage is not only economic but also reputational: being able to tell customers that the cheese on the table comes from a dairy a few kilometers away, or that the salad greens were harvested that very morning at a nearby farm, represents an added value that strengthens the image of restaurants and hotels. Digi-
tal short supply chains also address the growing demand for transparency, since traceability tools such as blockchain offer concrete guarantees on product origin and quality.
In this scenario, the short supply chain is no longer a utopia but a scalable, sustainable model perfectly aligned with a market that demands quality, authenticity, and responsibility. It is an opportunity that unites producers and food service professionals in a virtuous circle that looks to the future without forgetting its roots.


Very digestive, pleasantly spicy if properly diluted. It is alcohol free, but it gives a sensation as if it also contained alcohol. It is also an excellent aromatic appetizer.
It is produced without using sucrose sugar, in place of which fructose is used.
Fructose has a glycemic index of 25; while sucrose has a glycemic index of 65.
It has a 4.5% content of soluble fibers (acacia and baobab): soluble fibers are known for their ability to reduce blood sugar. This characteristic makes the product usable by the general public.


Molto digestivo, piacevolmente piccante se correttamente diluito. E’ analcolico, ma dà una sensazione come se contenesse anche alcool. E’ anche un ottimo aperitivo aromatico.
Viene prodotto senza usare zucchero saccarosio, in sostituzione del quale viene usato il fruttosio. Il fruttosio ha un indice glicemico di 25; mentre il saccarosio ha un indice glicemico di 65.
Ha un contenuto del 4,5% in fibre solubili (acacia e baobab): le fibre solubili, sono note per la loro capacità di ridurre la glicemia. Questa caratteristica, rende il prodotto utilizzabile dal grande pubblico.
Detox, preso al mattino, grazie alla combinazione di zenzero, curcuma, limone e spezie.
Utilizzo:
Diluito con acqua frizzante fredda; diluito con acqua bollente in inverno: come infuso, tisana, the; miscelato nei cocktails in piccole quantità; aggiunto alla birra al momento; aggiunto al gelato ed ai dessert, in poche gocce o con uno spruzzo. In inverno in acqua bollente come the o tisana
Detox, taken in the morning, thanks to the combination of ginger, turmeric, lemon and spices.
Use:
Diluted with cold sparkling water; diluted with boiling water in winter: as an infusion, herbal tea, tea; mixed in cocktails in small quantity; added to beer at the moment; added to ice cream and desserts in a few drops or with a splash. In winter with hot water as an herbal tea
Dilutions:
1 part GINGERIK with 20 parts of still water, morning detox
1 part GINGERIK with 7 parts of cold sparkling water: excellent digestive
1 part GINGERIK with 12 parts of cold sparkling water: excellent aperitif
1 part GINGERIK with 15 parts of boiling water, in winter: digestive and balsamic effect
It lasts 3 years in a closed bottle and over 60 days after opening, kept in the fridge.
The European research body E.M.A. has recognized ginger as having numerous health benefits, such as: antiemetic (travel by ship, plane, boat and car); anti-inflammatory; digestive; antioxidant; antithrombotic; anticholesterolemic; slimming on fat mass; hypoglycaemic; cardioprotective; anti-infective and much more.
For further information: EMA/ HPMC 577856 2010 Committee on Herbal medicinal products, Assessment Report on Zinziber Officinalis Roscoe Rhizome.
www.gingerik.com





Diluizioni:
1 parte di GINGERIK con 20 parti di acqua naturale, detox del mattino
1 parte di GINGERIK con 7 parti di acqua frizzante
fredda: ottimo digestivo
1 parte di GINGERIK con 12 parti di acqua frizzante
fredda: ottimo aperitivo
1 parte di GINGERIK con 15 parti di acqua bollente, in inverno: effetto digestivo e balsamico
Dura 3 anni in bottiglia chiusa ed oltre 60 giorni dopo l’apertura, tenuto in frigo.
L’ente europeo di ricerca E.M.A. ha riconosciuto allo zenzero numerose caratteristiche salutistiche quali: antiemetico (viaggi in nave, aereo, barca ed auto); antinfiammatorio; digestivo; antiossidante; antitrombotico; anticoleterolemizzante; dimagrante sulla massa grassa; ipoglicemizzante; cardioprotettivo; antinfettivo e molto altro.
Per ulteriori approfondimenti:
EMA/HPMC 577856 2010 Committee on Herbal medicinal products, Assessment Report on Zinziber Officinalis Roscoe Rhizome.
www.gingerik.com


For over fifty years, WELL Alimentare Italiana Srl has been a symbol of excellence in the world of granular and concentrated broths, culinary bases, and flavor enhancers.
Based in Casale sul Sile, in the province of Treviso, the company was born from a simple yet powerful gesture by its founder: creating a high-quality broth for the whole family.
Mission and Values
WELL believes in craftsmanship, uncompromising quality, and continuous innovation. Its mission is clear: to help professionals achieve superior taste performance through practical, versatile, and healthy solutions.
The company constantly monitors market trends and offers products that blend Italian culinary tradition with the most modern production technologies.






For the foodservice sector, WELL offers the “Chef to Chef” line: a complete range of granular broths, cooking stocks, culinary bases, flavor enhancers, and thickeners, specifically designed to support chefs with high-quality, tailor-made solutions. This premium line is available in versions with or without monosodium glutamate, gluten-free, lactose-free, GMO-free, and free from artificial flavorings. Naturalness and authentic taste are at the heart of WELL’s philosophy.
In the industrial sector, WELL stands out as a strategic partner for leading food companies, providing high-performance products and customized solutions: granular broths, stocks, natural concentrated bases, and innovative thickeners, all developed to ensure clean labels and stability even in the most complex processes.
With the support of its in-house research lab, the company develops tailor-made aromatic solutions, ensuring the highest standards of hygiene, safety, quality, and application performance.


The offering includes flexible formats (bags, buckets, jars) and a wide variety of natural flavors — beef, chicken, vegetables, fish, and mushrooms — ideal for ready meals, sauces, fillings, and soups. Certified ISO 9001 and ICEA for organic
production, WELL Alimentare continues to innovate, bringing passion and expertise to the service of Italian taste, all over the world.
wellalimentare.it

There is a thread that binds together tradition, territory, and passion: it is the thread of pasta created every day at Pastificio Artusi. A company that has made quality its mission, specializing in fresh egg pasta, filled pasta, and bronze-drawn pasta.
Its story is rooted in the heart of Padua, a city of art and science, where the culture of food has always been a distinctive mark. Here, in the evocative “Sotto il Salone” gallery of the Palazzo della Ragione, Alberto and Enrico Artusi embraced the legacy of the historic Pastificio Nello, active since the 1950s, and transformed it into a landmark for high-quality gastronomy. Every recipe is born from meticulous craftsmanship and a constant pursuit of excellence.
Artusi pasta is the result of a perfect balance between tradition, expertise, and innovation, bringing to the table authentic flavors that

PASTIFICIO ARTUSI: L’ARTE DELLA PASTA ITALIANA
C’è un filo che lega tradizione, territorio e passione: è il filo di pasta che nasce ogni giorno nel Pastificio Artusi. Un’azienda che ha fatto della qualità la sua missione, specializzandosi nella produzione di pasta fresca all’uovo, pasta ripiena e pasta trafilata al bronzo.
La storia affonda le radici nel cuore di Padova, città di arte e scienza, dove la cultura del cibo è da sempre un tratto distintivo. Qui, nella suggestiva galleria “Sotto il Salone” del Palazzo della Ragione, Alberto ed Enrico Artusi hanno raccolto l’eredità dello storico Pastificio Nello, attivo dagli anni ‘50, trasformandola in un punto di riferimento per la gastronomia di qualità.
Ogni ricetta nasce da una lavorazione artigianale attenta e dalla costante ricerca di eccellenza. La pasta Artusi è il frutto di un equilibrio tra manualità, esperienza e innovazione, capace di portare sulle tavole sapori autentici e memorabili. Non si tratta soltanto di custodire il patrimonio della tradizione, ma anche di rileggerlo in

leave a lasting impression. It is not only about preserving heritage, but also about reinterpreting it in a contemporary way. Alongside shapes that celebrate Veneto’s culinary roots, you will find specialties that showcase Italian regional traditions as well as original creations born from bold and imaginative combinations
This philosophy gives life to extraordinary products such as the Ravioli Euganei with wild boar or the Ravioli del Doge with cod and white polenta, which pay tribute to Italian culinary heritage, or the Ravioli Patavini with chicken, deeply tied to Padua’s local tradition, up to sea-inspired specialties such as Ravioli with blue king crab from the Adriatic.
Behind every shape and every filling lies a value that goes beyond flavor: passion. The same passion that guides every step, from kneading to finishing, and that turns Artusi pasta into an experience capable of telling the story, culture, and taste of Italy.
Pastificio Artusi: the passion for fresh pasta that carries the scent of Italy.
www.pastificioartusi.com




chiave contemporanea. Accanto ai formati che celebrano le radici venete, convivono infatti specialità che raccontano le diverse regioni italiane e proposte creative nate dall’incontro di ingredienti e combinazioni originali.
Così nascono prodotti straordinari come i Ravioli Euganei con cinghiale o i Ravioli del Doge con baccalà e polenta bianca, che richiamano la migliore tradizione italiana o i Ravioli Patavini con carne di gallina, che richiamano la storia gastronomica locale, fino a suggestioni di mare come i Ravioli con polpa di granchio reale blu dell’Adriatico.
Dietro ogni formato e ogni ripieno c’è un valore che non si misura solo in sapore: è la passione.
La stessa che accompagna ogni gesto, dall’impasto


For generations we live in Farigliano, a small village located on the first hills of the Langhe, in Piedmont. Here, at the beginning of the twentieth century, great-grandfather Luigi and his son Giuseppe began to cultivate a small vineyard of Dolcetto grapes. Aldo, Giuseppe’s son and current owner of the winery with his wife Gianfranca and daughters, Luisa and Paola, today run the company, helped by capable collaborators. For over a century we cultivate vineyards and produce wine without losing sight of our roots and the care for the quality and sustainability of the territory in which we live.
We produce the great Piedmontese reds such as Barolo, Barbaresco, Nebbiolo, Barbera and Dogliani and the whites, including Gavi, Chardonnay, Arneis, Moscato d’Asti, Asti Spumante and the classic method Alta Langa.
Sustainability is a concrete commitment: the photovoltaic system installed on the roof of our winery allows us to be self-sufficient. Water saving is ensured by an artesian well owned by the farm, about 300 meters deep. Cardboard boxes and labels have the FSC® certification, which guarantees that the paper used comes from responsibly managed forests. In the vineyards, the work is done by hand, without the use of machinery that would cause trauma to the plant, greater pollution and disturbance to wild animals. We work following a virtuous circular economy for the recovery, for example, of the grape skins, used by a local cheese factory, and the stalks, donated to local farmers who transform them into beds for their calves.
At our BRICCO ROSSO farm we offer hospitality and experiences. The view from here is truly unique: surrounded by vineyards and the Alps.

MANFREDI: TRADIZIONE, QUALITÀ E SOSTENIBILITÀ NEL CUORE DELLE LANGHE
Da generazioni viviamo a Farigliano, un piccolo paese adagiato sulle prime colline delle Langhe, in Piemonte. Qui, all’inizio del Novecento il bisnonno Luigi e suo figlio Giuseppe iniziarono a coltivare un piccolo vigneto di uva Dolcetto.
Aldo, figlio di Giuseppe e attuale proprietario della cantina con la moglie Gianfranca e le figlie, Luisa e Paola, oggi conducono l’azienda, aiutati da capaci collaboratori. Da oltre un secolo coltiviamo vigneti e produciamo vino senza perdere di vista le nostre radici e la cura per la qualità e la sostenibilità del territorio nel quale viviamo.
Produciamo i grandi rossi piemontesi come Barolo, Barbaresco, Nebbiolo, Barbera e Dogliani e i bianchi, tra cui Gavi, Chardonnay, Arneis, Moscato d’Asti, Asti Spumante e il metodo classico Alta Langa.
La sostenibilità è un impegno concreto: l’impianto fotovoltaico installato sulla copertura della nostra cantina ci permette di essere autosufficienti. Il risparmio idrico è assicurato da un pozzo artesiano di proprietà, profondo circa 300 metri.
Cartoni ed etichette hanno la certificazione FSC® che garantisce che la carta utilizzata proviene da foreste gestite in maniera responsabile. Nei vigneti i lavori sono eseguiti a mano, senza l’utilizzo di macchinari che porterebbero traumi alla pianta, maggiore inquinamento e disturbo agli animali selvatici. Lavoriamo seguendo una virtuosa economia circolare per il recupero, ad esempio, delle bucce degli


The rooms are very large, with a wonderful view. The warm welcome, the tranquility of the place and the goodness of our wines allow guests to fully immerse themselves in the pleasures of the Langhe.
www.manfredicantine.it
acini, utilizzate da un caseificio locale, e dei raspi, donati ad allevatori locali che li trasformano in giacigli per i loro vitellini.
Nella nostra azienda agricola BRICCO ROSSO offriamo ospitalità ed esperienze. Il panorama da qui è davvero unico: circondati dai vigneti e dalle Alpi.
Le camere sono molto ampie, con una vista meravigliosa.
La calda accoglienza, la tranquillità del luogo e la bontà dei nostri vini permettono agli ospiti un’immersione totale nei piaceri delle Langhe.
www.manfredicantine.it






When talking about Cantine Lombardini, one cannot help but recall a heritage of now 100 years of history, intertwined with passion, innovation and an unconditional love for Lambrusco. In 1925, grandfather Angelo founded Cantine Lombardini in the historical centre of Novellara, still located in the original premises.
A century of history and four generations, but it is not only history that makes us unique: what distinguishes our work in the world of Lambrusco is constant qualitative improvement. The search for more advanced technologies has led us to an avant-garde production system, inspired by the techniques used for great red wines.
Our winery is the only one in the Lambrusco scene to use a production system typical of areas outside our region, a method that has its roots with GAI in Alba, Piedmont.
This strategic investment has enabled us to significantly improve the longevity of our Lambrusco wines, while keeping their freshness and elegance intact, qualities that are clearly evident in the awards we have received.

100 ANNI DI LAMBRUSCO LOMBARDINI: UN CENTENARIO DI QUALITÀ E
Quando si parla di Cantine Lombardini, non si può fare a meno di ricordare un patrimonio di ormai 100 anni di storia, intrecciato con passione, innovazione e un amore incondizionato per il Lambrusco.
Nel 1925 il nonno Angelo fondò nel centro storico di Novellara le Cantine Lombardini, situate ancora oggi nella sede originaria.
Un secolo di storia e quattro generazioni, ma non è solo la storia a renderci unici: ciò che distingue il nostro lavoro nel mondo del Lambrusco è un costante perfezionamento qualitativo.
La ricerca di tecnologie più avanzate ci ha portato ad avere un sistema produttivo d’avanguardia, ispirato alle tecniche impiegate per i grandi vini rossi.


One of the most important moments in our recent history dates back to 2019, when Il Campanone brought Lambrusco to the highest podium of the Champagne & Sparkling Wine World Championships (CSWWC), the most prestigious international competition dedicated to bubbles. For the first time, Lambrusco won a place of honour alongside the great names of the wine world, demonstrating that our wine not only competes, but excels globally with its uniqueness. In Italy, too, our Lambruscos continue to receive top accolades, confirming our dedication to quality.
Each bottle tells our story and our commitment to a product that is a symbol of our territory and our vision, striving for excellence.
www.lombardinivini.it




La nostra Cantina è l’unica nel panorama del Lambrusco a utilizzare un sistema produttivo tipico delle zone fuori dalla nostra regione, un metodo che trova le radici con GAI a Alba, in Piemonte. Questo investimento strategico ci ha permesso di migliorare significativamente la longevità dei nostri Lambruschi, mantenendone intatta la freschezza e l’eleganza, qualità che emergono chiaramente nei riconoscimenti ottenuti.
Uno dei momenti più importanti della nostra storia recente risale al 2019, quando Il Campanone ha portato il Lambrusco sul podio più alto dello Champagne & Sparkling Wine World Championships (CSWWC), la competizione internazionale più prestigiosa dedicata alle bollicine.
Per la prima volta, il Lambrusco ha conquistato un posto d’onore accanto ai grandi nomi del mondo enologico, dimostrando che il nostro vino non solo compete, ma eccelle a livello globale con la sua unicità.
Anche in Italia i nostri Lambruschi continuano a ricevere riconoscimenti di spessore, confermando la nostra dedizione alla qualità.
Ogni bottiglia racconta la nostra storia e il nostro impegno per un prodotto che sia simbolo del nostro territorio e della nostra visione, puntando all’eccellenza.
www.lombardinivini.it



Rooted in the Franciacorta region, Freccianera tells a story of authenticity, respect for the land and a contemporary vision. In this interview, the winery shares how tradition and innovation can coexist— through concrete sustainability, a recognisable style, and a growing presence on international markets.
Your bond with Franciacorta is deep and distinctive: how do you interpret this region?
It’s the core of our philosophy. We stay true to the traditional viticulture methods that made this area famous, but enrich them with a personal approach. Modern techniques and artisanal sensitivity allow us to fully express the soul of the terroir.
Sustainability is one of your founding values: what practices do you adopt?
We are SQNPI certified and apply integrated pest management across 70 hectares, always respecting natural rhythms. Our commitment protects biodiversity and ensures high-quality grapes, without compromising on competitiveness or environmental ethics.
Your Franciacorta wines express different personalities but a common identity: how do you achieve this?
Through careful grape selection and tailored vinification for each harvest. The common thread is the balance between elegance and complexity, a signature that makes each Freccianera label instantly recognisable.
Radicata in Franciacorta, Freccianera racconta una storia fatta di autenticità, rispetto per la terra e visione contemporanea. In questa intervista, la cantina spiega come tradizione e innovazione possano convivere, attraverso una sostenibilità concreta, uno stile riconoscibile e una presenza in crescita sui mercati internazionali.
Il vostro legame con la Franciacorta è profondo e distintivo: come interpretate questo territorio?
È il cuore della nostra filosofia. Restiamo fedeli ai metodi tradizionali che hanno reso celebre questa zona, ma li arricchiamo con un approccio personale. Tecniche moderne e sensibilità artigianale ci permettono di esprimere al meglio l’anima del terroir
La sostenibilità è uno dei vostri valori fondanti: quali pratiche adottate?
Siamo certificati SQNPI e applichiamo la lotta integrata su 70 ettari, sempre nel rispetto dei ritmi naturali. Questo impegno protegge la biodiversità e garantisce uve di alta qualità, senza compromessi sulla competitività né sull’etica ambientale.
I vostri Franciacorta esprimono personalità diverse ma un’identità comune: come ci riuscite?
Attraverso una selezione accurata delle uve e una vinificazione su misura per ogni vendemmia.


How do you communicate the artisanal value behind each bottle?
We share our work through digital platforms, guided tastings, and winery visits. By telling the story behind each step of the process, we turn every bottle into an engaging and meaningful experience.
You’re focused on both the horeca channel and exports: what strategies are you pursuing?
In Italy, we work with top restaurants and wine bars that share our passion for excellence. Abroad, we focus on selected markets that align with our style. Our strategy is to preserve brand authenticity while adapting to the specific needs of each region.
www.freccianera.it





Il filo conduttore è l’equilibrio tra eleganza e complessità, una firma che rende ogni etichetta Freccianera immediatamente riconoscibile.
Come comunicate il valore artigianale dietro ogni bottiglia?
Condividiamo il nostro lavoro attraverso i canali digitali, degustazioni guidate e visite in cantina. Raccontiamo ogni fase del processo, trasformando ogni bottiglia in un’esperienza coinvolgente e significativa.
Guardate sia al canale horeca che all’export: quali strategie state seguendo?
In Italia collaboriamo con ristoranti ed enoteche di qualità che condividono la nostra passione per l’eccellenza. All’estero ci concentriamo su mercati selezionati, affini al nostro stile. La nostra strategia è mantenere l’autenticità del marchio, adattandoci alle esigenze specifiche di ogni area.
www.freccianera.it


Situated in Refrontolo (TV), in the middle of the prestigious Prosecco Superiore area of Conegliano-Valdobbiadene, Colvendrà has recently celebrated the 100th anniversary since its foundation: in the early 1900s, Leonardo Della Colletta – also called “Bepi”starting from the production of rootstock cuttings, selecting those capable of transmitting the best aromas and flavours, gave birth in 1924 to the wine and vineyard estate Colvendrà, today famous not only for its Prosecco Superiore but also for its Colli di Conegliano Rosso and “Refrontolo Passito”; our wines are deeply appreciated for their significant structure and personality.


UNA TRADIZIONE CENTENARIA
Colvendrà, situata a Refrontolo (TV), nel cuore del Veneto, al centro della prestigiosa area del Prosecco Superiore di Conegliano-Valdobbiadene, ha recentemente festeggiato il centenario dalla sua fondazione: nei primi del Novecento, Leonardo Della Colletta - detto Bepi - partendo dalla produzione di barbatelle porta-innesto, selezionando poi quelle in grado di trasmettere i migliori profumi e sapori, diede vita nel 1924 all’azienda vitivinicola, oggi famosa non solo per il Prosecco Superiore, ma anche per il Colli di Conegliano Rosso ed il Refrontolo Passito; i nostri vini sono infinitamente apprezzati per la loro importante struttura e personalità.
La produzione è ampia e variegata e spazia da vini bianchi e rossi tranquilli, al Prosecco da DOC a DOCG nelle varie versioni (frizzante e spumanti brut, extra dry, dry), a spumanti ottenuti da uve autoctone come il verdiso e l’incrocio Manzoni 6.0.13, agli spumanti rosati, ai passiti di marzemino e di glera, al rosso di punta il Col de Ciso, recentemente bev food

The production is wide and varied, ranging from white and red still wines to Prosecco DOC and DOCG in various versions (semi-sparkling and sparkling in brut, extra dry, dry), to sparkling of indigenous grapes such as “Verdiso” and “Incrocio-Manzoni 6.0.13”, to sparkling rosè, to passito wines of Marzemino and Glera grapes, to the flagship red “Col de Ciso” fresh of winning the Grand Gold Medal at the global extreme-wine contest (as proof of these hills being historically capable of prestigious red wines, like the marzemino praised in Mozart’s “Don Giovanni”).
In this extraordinary land, the pedo-climatic conformation of the area, favours the optimal sun exposure of the vineyards, shielding them from the northern cold winds thanks to the backdrop of the Pre-




Alps, which creates a beautiful landscape. The clayish soil grants the vineyard with harmonious growth and productivity, infusing it with complex elements.
The family tradition is now in the hands of the grandson Giuseppe and sons, who together run the business with the same passion and dedication in the vineyard as in the winery
The respect for the environment and the preservation of the landscape remains a treasured legacy for Colvendrà, especially of values: even today the vineyards are harmoniously alternated with hedges and tiny woods, creating a unique natural setting of rare beauty.
Visit: www.colvendra.it

insignito della gran medaglia d’oro al concorso mondiale dei vini estremi (a conferma che storicamente queste terre erano terre da grandi rossi, come il marzemino decantato nel Don Giovanni di Mozart).
In questa terra straordinaria, la conformazione pedo-climatica dell’area favorisce l’ottimale esposizione dei vigneti al sole e li ripara dai venti freddi del Nord grazie alla corona delle Prealpi che ne fanno da sfondo suggestivo; il terreno argilloso conferisce alla vigna ottimale equilibrio vegeto-produttivo e ne trasferisce importanti e complessi elementi.
La tradizione di famiglia è ora nelle mani del nipote Giuseppe e dei figli, che conducono l’attività con la stessa passione e dedizione, sia in vigna che in cantina. Il rispetto dell’ambiente e del contesto paesaggistico rimane per Colvendrà una preziosa eredità, soprattutto di valori: ancora oggi le vigne sono armoniosamente alternate da siepi e piccoli boschi che disegnano un contesto naturale unico di rara bellezza.
Visita: www.colvendra.it

Slow Wine Fair, the only international exhibition dedicated to good, clean and fair wine, returns for its fifth edition at BolognaFiere from Sunday 22 to Tuesday 24 February 2026.
Organised by BolognaFiere and based on a concept by Slow Food, the Slow Wine Fair promotes wines from sustainable agriculture, respectful of biodiversity and the agricultural landscape, and aimed at both the socio-cultural growth of farming communities and raising consumer awareness.
The success of the 2025 edition was decreed by 15,000 entries, 80% of which were Horeca operators, distributors and importers, who appreciated the high quality of the wines on offer: over 1,000 wineries on display (+18% compared to 2024), with 157 international producers, and more than 6,000 labels (+15%). Thanks to the support of ITA - Italian Trade Agency and the Ministry of Foreign Affairs, 300 buyers from 20 countries converged at BolognaFiere, creating the opportunities for winemakers and vignerons to access new markets.
The selection of wineries, hundreds of which have already signed up for Slow Wine Fair 2026, has to meet the requirements set out in the Slow Food Manifesto of good, clean and fair wine, the Slow Wine Guide and the assessments of a tasting commission.


La quinta edizione di Slow Wine Fair, l’unica fiera internazionale dedicata al vino buono, pulito e giusto, si tiene a BolognaFiere da domenica 22 a martedì 24 febbraio 2026.
Organizzata da BolognaFiere a partire da un’idea di Slow Food, la Slow Wine Fair promuove i vini da agricoltura sostenibile, rispettosa della biodiversità e del paesaggio agrario, e tesa sia alla crescita socioculturale delle comunità contadine che a rendere i consumatori più consapevoli.
Il successo dell’edizione 2025 è stato decretato da 15.000 ingressi, l’80% dei quali di operatori dell’Horeca, distributori e importatori, che hanno apprezzato l’elevata qualità dei vini proposti: oltre 1.000 le cantine presenti (+18% rispetto al 2024), con 157 produttori internazionali, e più di 6.000 le etichette (+15%). E con il supporto di ICE - Agenzia e del Ministero degli Affari Esteri, a BolognaFiere sono confluiti 300 buyer da 20 Paesi, creando le premesse per l’accesso di vignaioli e vignerons a nuovi mercati.
La selezione delle cantine, che hanno già aderito a centinaia alla Slow Wine Fair 2026, risponde ai requisiti fissati nel Manifesto Slow Food del vino buono, pulito e giusto, alla Guida Slow Wine e alle valutazioni di una commissione d’assaggio.
Sempre sold out nel 2025, tornano le masterclass e i convegni Tema portante, il vino come motore di inclusione e di sviluppo sociale: un’occasione per esplorare il ruolo della viticoltura come strumento di integrazione dei lavoratori stranieri, di partecipazione di donne e giovani, e di rigenerazione territoriale.
Tra le conferme, i torrefattori della Slow Food Coffee Coalition, i produttori di sidro e i partner della sostenibilità, con tecnologie, impianti, attrezzature e servizi all’avanguardia legati alla filiera del vino sostenibile.
Per il secondo anno consecutivo, in contemporanea a Slow Wine Fair si svolge SANA Food, il concept di BolognaFiere che mette in connessione i buyer dell’Horeca, dei negozi specializzati e del risto-retail con le più innovative ed etiche imprese agroalimentari di prodotti sani e sostenibili, biologici, DOP, IGP e STG.
slowinefair.it

Following last year’s sold out, masterclasses and conferences are back. The main theme in 2026 will be wine as a driver of inclusion and social development: an opportunity to explore the role of viticulture as a tool for integrating foreign workers, promoting the participation of women and young people, and regenerating the local area.
Among those confirmed are the roasters of the Slow Food Coffee Coalition, cider producers and sustainability partners, with cutting-edge technologies, systems, equipment and services related to the sustainable wine supply chain.
For the second consecutive year, SANA Food will be held concurrently with the Slow Wine Fair. The BolognaFiere event connects buyers from the Horeca sector, specialised shops and restaurant-retailers with the most innovative and ethical agri-food companies offering healthy and sustainable, organic, PDO, PGI and TSG products.
slowinefair.slowfood.it/en/





Great expanses of olive trees, tablelands furrowed by the man’s hand and bright chromatisms are the frames of the characteristic town of TERLIZZI, in the north of Bari. It’s here that our family’s roots are and where the family started the manufacture of a “nectar” called extra virgin olive oil in 1953
Their attachment to tradition and their attention to the changes of time make the Luglio’s firm a point of reference for the working process of the Baresan oil, the most esteemed in the world by experts. The control of the countryside cultivation, the bottling process and the finished products trade are the pride of the Luglio’s.
The extraordinary experience handed down from father to son, guarantees the genuineness, deliciousness and high quality of this oil, “the good of Italy”.
Medsol s.r.l is one of the biggest bottler companies in PDO Terra di Bari Extra Virgin olive oil PDO “TERRA DI BARI” EXTRA VIRGIN OLIVE OIL. (The Protected Designation of Origin) is the important recognition for the value and the quality by which the European Community assures customers about the geographical area of origin and the uniqueness of olive oil production methods in “Terra di Bari”.
Environmental conditions and the cultivation methods make our “Terra di Bari” PDO extra virgin olive oil a precious oil. Luglio considers very important the traditional ways of cultivating and pruning olives in order to preserve all their original characteristics. In our range, you can find also “Gold Selection” extra virgin olive oil obtained only from 100% Italian olives. This kind of oil has an intense aroma, which reminds to one of the olives harvested from the plant at the right degree of ripeness. The characteristic of 100% Italian extra virgin olive oil ‘’Gold Selection’’ is the balance between bitter and spicy, of medium intensity.
Medsol srl has many certifications such as: ISO 22005, IFS, BRC, KOSHER, HALAL, ORGANIC and P.D.O.
www.olioluglio.it
OLIO LUGLIO, DAL 1953
L’attenzione e la disponibilità verso i Clienti e la passione per l’olio extra vergine di oliva (EVO), prodotto principe della Nostra Terra, sono i valori su cui la Famiglia Luglio fonda la sua attività.
Si tratta di una storia d’amore iniziata nel lontano 1953, con la coltivazione e la produzione di olio EVO di alta qualità, ed evolutasi nel corso degli anni con l’ambizione di promuovere e condividere i Nostri prodotti per eccellenza con tutte le persone che vogliano apprezzarne i sapori e la storia, accorciando le distanze. La necessità di essere al passo coi tempi, senza rinunciare alla salvaguardia dell’ambiente, e la volontà di realizzare le esigenze di ciascun Cliente, sempre più sensibile e attento alla salute e alla natura, hanno portato la Famiglia Luglio, fondatrice della Medsol srl, a puntare sull’imbottigliamento di vari tipi di olio, tra cui spiccano per autenticità e per


le note proprietà benefiche, l’olio EVO D.O.P. (denominazione di origine protetta), l’olio extravergine di oliva “Selezione Oro” viene ottenuto da olive 100% italiane e l’olio extravergine di oliva biologico 100% Italiano.



La denominazione di origine protetta (D.O.P.) è l’importante riconoscimento del pregio e della qualità con cui la Comunità Europea garantisce ai consumatori la zona di origine e la tipicità del nostro olio extravergine di oliva prodotto in “Terra di Bari”.
Le condizioni ambientali e le metodologie di coltura degli oliveti nella nostra provincia barese conferiscono all’olio DOP quelle caratteristiche peculiari che ne fanno un olio extravergine di oliva pregiatissimo.
I metodi di coltivazione e i sistemi di potatura devono essere quelli tradizionali, atti a mantenere originali le caratteristiche delle olive. All’interno della gamma dei prodotti ‘’LUGLIO’’ vi è l’olio extra vergine di oliva “Selezione Oro” ottenuto da olive 100% italiane.
Questo olio è caratterizzato da un profumo intenso, che restituisce quello delle olive raccolte dalla pianta al giusto grado di maturazione La particolarità dell’olio extra vergine 100% italiano ‘’Selezione Oro’’ è l’equilibrio tra amaro e piccante, di media intensità.
Medsol s.r.l fornisce ai clienti italiani e internazionali la stessa attenzione alla qualità, garantendo la piena tracciabilità dei prodotti.
Medsol s.r.l dispone di certificazioni quali: ISO 22005, IFS, BRC, KOSHER, HALAL, BIOLOGICO e D.O.P
www.olioluglio.it

Pasta Fresca Morena is a historic artisan pasta factory in Ventimiglia, born more than 50 years ago.
In all this time he has been able to keep up with the times by modernizing the machinery in his laboratory and continuing the family tradition by producing fresh pasta and condiments with fresh and genuine ingredients.
Among the specialties that are produced we remember the Ravioli of borage; stuffed Gnocchi; Trofie; Cappelletti; Cannelloni ricotta and spinach, meat and vegetables; Chicche with mushrooms, basil, and greens; Bassottini; Fusilli; Gigli; Lasagne; Orecchiette; Pansotti and Ravioli filled with both fish, vegetables and fruit. Sauces are also prepared to accompany fresh pasta and also Russian salad and veal with tuna sauce.



Pasta Fresca Morena is in Via Aprosio 21/c and box n.15 of the covered market of Ventimiglia, in the Province of Imperia.
The company’s mission is to continue to offer products of the highest quality at a market price accessible to all; private and commercial activities. The pasta factory today counts a milestone of four generations. We boast many regional awards as master craftsmen and we are present in the territory that starts from nearby France to all the Western Liguria. www.pastafrescamorena.it





+39 0184 33461 info@pastafrescamorena.it www.pastafrescamorena.it
• Via Aprosio 21/c Ventimiglia
• Mercato coperto di Ventimiglia Box n.15
• Mercato coperto di Bordighera Box n.20
• Via Maraldi 17 Perinaldo



From 2020 Fiorentini Firenze S.p.A is on the market with three new products of the “Climate Friendly” family: Extra Virgin Olive Oil, 100% Italian, the flagship of the company’s production, not only accompanied by a specific certificate of traceability for each bottle, but “capable of respecting the environment” with a zero climate impact thanks to the offsetting of carbon emissions.
Founded in 1996, Fiorentini Firenze has over time specialized in providing a service of processing, bottling, packaging and storage of extra virgin olive oil for a wide range of customers that now includes the most important Italian and European GD and GDO chains, as well as the main multinational groups in the food sector. The new production site in Colle di Val d’Elsa (SI), inaugurated in 2017, consists of a 250 square meter analysis laboratory and an oil storage center of about 15 million liters. The bottling plant consists of 6 lines with an average daily production capacity of about 200,000 bottles; the product storage department is equipped with 2000 pallet places with four covered loading bays.
In 1998 the company approached the foreign market, first with the US market, followed by the German market in 2001. Since then, the development performance increases by more than 20% every year, so that at the end of 2015 the total number of packaged bottles is over 43,500,000 units, with sales for 70% on international markets, mainly consisting of Germany, USA,


FIORENTINI FIRENZE PRESENTA LA NUOVA
LINEA DI PRODOTTI “CLIMATE FRIENDLY”
Dal 2020 Fiorentini Firenze S.p.A è sul mercato con tre nuovi prodotti della famiglia “Climate Friendly”: Olio Extravergine di Oliva, 100% Italiano, fiore all’occhiello della produzione aziendale, non solamente corredato di un certificato di tracciabilità specifico per ogni bottiglia, ma “capace di rispettare l’ambiente” con un impatto climatico pari a zero grazie alla compensazione delle emissioni di carbonio
L’AZIENDA FIORENTINI FIRENZE
Fondata nel 1996 Fiorentini Firenze si è nel tempo specializzata per fornire un servizio di lavorazione, imbottigliamento, confezionamento e stoccaggio di olio extra vergine di oliva per una vasta clientela che annovera oggi le più importanti catene della GD e GDO italiana ed europea,

Brazil, France, Japan, China, Russia, England, Switzerland and the remaining 30% on domestic markets.
As of today, 2020, the annual production exceeds 50,000,000 bottles between private label and the three company brands ANTICO FRANTOIO, OLIVETA, FIORENTINI FIRENZE.
The company’s objective is to increase the volume of exports to the foreign market by up to 70%, through products increasingly aimed not only at underlining its importance in large-scale distribution but also at acquiring an increasingly strong identity in the eyes of the end consumer: the values with which Fiorentini Firenze has grown over the years are and will always be a guarantee of quality.
Quality not only in the excellence and in the control of the raw material to be used but also the quality of the production chain itself, based now more than ever on new technologies, on eco-sustainability and ethical and social responsibilities
The company Fiorentini Firenze S.p.A invests a lot in technological innovation and sustainable energies: the storage facilities are one of the first facilities in Italy to provide the new technology of Conservation under nitrogen and processing with Cold Cycle, and the entire operational management center uses photovoltaic and geothermal energy systems for at least 40% of its energy needs. With the recent construction of the new plant, the company also pays particular attention to the issue of sustainability, a balance between the development of its economic activity and the protection of the environment, thus becoming an excellence in the oil industry not only for the high standard of production but also because, aware of its commercial importance, it invests to eliminate the climate impact of its work and launches new Climate Friendly products on the market.
For the first time in Europe an Italian company quanti-

nonché i principali gruppi multinazionali del settore alimentare. Il nuovo stabilimento di produzione di Colle di Val d’Elsa (SI), inaugurato nel 2017, è composto da un laboratorio di analisi di 250 mq e di un centro di stoccaggio di olio da 15 milioni di litri c.ca.
L’imbottigliamento è costituito da 6 linee con capacità produttiva media giornaliera di circa 200.000 bottiglie; il reparto di stoccaggio prodotti è provvisto di 2000 posti pallet con quattro baie di carico coperte
LA CRESCITA, VERSO IL FUTURO Nel 1998 l’azienda si approccia con il mercato estero, prima con il mercato Usa, a cui segue dal 2001 il mercato tedesco
Dal quel momento, la performance di sviluppo incrementa di oltre il 20% ogni anno, tanto che a fine del 2015 il totale delle bottiglie confezionate va oltre i 43.500.000 di unità, con vendite per il 70% su mercati internazionali, costituiti principalmente da Germania, Stati Uniti, Brasile, Francia, Giappone, Cina, Russia, Inghilterra,
Svizzera e il restante 30% su mercati nazionali. Ad oggi, 2020, la produzione annuale supera le 50.000.000 bottiglie tra private label e i tre marchi aziendali ANTICO FRANTOIO, OLIVETA, FIORENTINI FIRENZE.
Obiettivo dell’azienda quello di incrementare i volumi di esportazione del mercato estero fino al 70%, attraverso prodotti sempre più mirati non solo a sottolineare la propria importanza nella grande distribuzione ma anche all’acquisizione di un’identità sempre più forte agli occhi del consumatore finale: i valori con cui Fiorentini Firenze cresce negli anni sono e saranno sempre garanzia di qualità.
Qualità non solo nell’eccellenza e nel controllo della materia prima da usare ma anche qualità della catena produttiva in sè, improntata adesso più che mai sulle nuove tecnologie, sull’ecosostenibilità e sulle responsabilità etiche e sociali
IL VALORE DELL’ INNOVAZIONE
L’azienda Fiorentini Firenze S.p.A investe molto sull’innovazione tecnologica e sulle ener-

fies and eliminates cO2 emissions by offsetting them with the program “PLANTING BIODIVERSE FOREST IN PANAMA” certified GOLD STANDARD: developed by Forest Finance and expanded by the partners Sustainable Timber and Isla Cebaco, the project is based on a system that combines the production of high-quality sustainable timber and cocoa with the protection of biodiversity and the restoration of the ecosystem. With the Climate Friendly products, Fiorentini does not only aim to sensitize the end-user through the choice of an eco-friendly product, but it takes first the responsibility to improve its environmental performance creating social promotion and economic self-sufficiency for local populations in developing countries.
GLOBAL EXPANSION AND RESPONSIBLE INNOVATION: FIORENTINI FIRENZE’S VISION FOR GROWTH
Fiorentini Firenze continues its path of global expansion in the extra virgin olive oil sector, focusing on strategic partnerships with major international retailers. To support this growth, the company is not only strengthening its research and development efforts to create innovative and sustainable products but also investing in expanding its production and storage capacity—ensuring greater efficiency and consistent quality.
The ultimate goal is to combine excellence, environmental responsibility, and the enhancement of local heritage, offering the market olive oils that embody tradition, innovation, and a deep commitment to sustainability.
www.fiorentinifirenze.it


gie sostenibili: l’impianto di stoccaggio è uno dei primi impianti in Italia a prevedere la nuova tecnologia di Conservazione sotto azoto e lavorazione con Ciclo del Freddo, e l’intero centro direzionale operativo utilizza impianti energetici fotovoltaici e geotermici per almeno il 40% del proprio fabbisogno energetico.
Con la recente costruzione del nuovo stabilimento, l’azienda presta inoltre particolare attenzione al tema della sostenibilità, equilibrio tra lo sviluppo della propria attività economica e la salvaguardia dell’ambiente, divenendo così eccellenza nell’industria olearia non solo per l’alto standard di produzione ma anche perché, conscia della propria importanza commerciale, investe per azzerare l’impatto climatico del suo operato e lancia sul mercato i nuovi prodotti Climate Friendly.
I PRODOTTI CLIMATE FRIENDLY, UNA PRESA DI RESPONSABILITA’
Per la prima volta in Europa un’azienda italiana quantifica ed azzera le emissioni di cO2 compensandole con il programma “PLANTING BIODIVERSE FOREST IN PANAMA” certificato GOLD STANDARD: sviluppato da Forest Finance e ampliato dai partner Sustainable Timber e Isla Cebaco, il progetto si basa su un sistema che combina la produ-
zione di legname e cacao sostenibili di alta qualità con la protezione della biodiversità e il ripristino dell’ecosistema.
Con i prodotti Climate Friendly Fiorentini non mira esclusivamente a sensibilizzare l’utente finale attraverso la scelta di un prodotto ecosostenibile, ma si assume per prima la responsabilità di migliorare le proprie performance ambientali creando promozione sociale ed autosufficienza economica per le popolazioni locali nei paesi in via di sviluppo.
ESPANSIONE GLOBALE E INNOVAZIONE RESPONSABILE: LA VISIONE DI CRESCITA DI FIORENTINI FIRENZE
L’azienda continua il suo percorso di espansione globale nel settore dell’olio extravergine di oliva, puntando su accordi strategici con la grande distribuzione internazionale. Per sostenere questa crescita, parallelamente al rafforzare la ricerca e sviluppo per creare prodotti innovativi e sostenibili, investe nell’aumento della capacità produttiva e di stoccaggio, garantendo efficienza e qualità. L’obiettivo è coniugare eccellenza, responsabilità ambientale e valorizzazione del territorio, offrendo al mercato oli d’oliva che uniscono tradizione, innovazione e attenzione alla sostenibilità..
www.fiorentinifirenze.it
A delicious, versatile source of creativity: these are the three strengths of the brand-new version of Bergader’s time-honoured blue-veined cheese, which has been used successfully for so many years in kitchens around the world, both in restaurants and at home, to create regional and international dishes.
Edelpilz, the classic cheese produced by the Bavarian company, which boasts 123 years of high-quality cheesemaking experience, is returning to the shelves as Edelblu and, alongside the Classic version, will be available in three, new, ready-to-use variants to meet any culinary requirements.
“Our historic products – first and foremost, Edelpilz – represent the perfect combination of the consolidated expertise of our master cheesemakers and our focus on consumer trends,” explains Diego Farinazzo, marketing director for Bergader Italia. For this reason, we have remained faithful to the quality that marks it out, maintaining the same recipe that has made it a staple in the kitchens of chefs and of many Italian households.”
Edelblu retains the characteristic colours of the 100g pack, making a strong, recognisable impact on the shelf, but now features a more

Gustoso, versatile e fantasioso. Nasce all’insegna di questi tre punti di forza la nuovissima versione dello storico formaggio erborinato di Bergader, con le sue caratteristiche venature blu, da sempre utilizzato con successo in tutte le cucine del mondo, sia nei ristoranti che a casa, per realizzare piatti regionali e internazionali.
Edelpilz, il grande classico dell’azienda bavarese che vanta 123 anni di tradizione casearia e qualità eccellente, torna oggi a scaffale come edelblu e, oltre che in versione Classic, sarà disponibile in tre nuove varianti pronte all’uso e adatte a qualsiasi esigenza culinaria.
«Le referenze storiche, prima fra tutte Edelpilz, rappresentano il connubio perfetto tra il saper fare antico dei maestri casari e l’attenzione ai trend di consumo – spiega Diego Farinazzo, Direttore Marketing Italia. Per questo motivo abbiamo deciso di rimanere fedeli alla qualità che lo contraddistingue, mantenendo la stessa ricetta che lo ha reso un prodotto indispensabile nelle cucine degli chef ma anche in quelle di tante famiglie italiane».
Edelblu ha infatti mantenuto i colori caratteristici della confezione da 100g,


modern, captivating graphic design, conceived not only to allow easy identification by existing customers but also to pique the curiosity of a new audience.
Alongside the Classic version, Bergader has created three variants intended to amaze lovers of blue cheese:
- edelblu Cream in the practical 175 g pack. Creamy and spreadable, thanks to a new recipe, it is ideal for both cold and hot dishes, unleashing creativity in the kitchen.
- edelblu Cubes in the innovative 2x50g pack that eliminates waste.
Practical and versatile, the 6mm cubes are perfect for making salads, pizzas, gratins and cold or oven-baked dishes.
- edelblu Gourmet in the 100g tray.
Refined and versatile, it is excellent as an ingredient but also delicious eaten cold or when used to enrich a cheeseboard.
www.bergader.it
ben riconoscibile e impattante a scaffale, ma si presenta con una grafica più moderna e accattivante, pensata per essere individuata facilmente dagli affezionati ma allo stesso tempo per intercettare e incuriosire un pubblico nuovo.
Alla versione Classic, Bergader ha deciso di affiancare tre varianti studiate per stupire gli amanti del Blue Cheese:
- edelblu Cream nella pratica confezione da 175 g. Cremoso e spalmabile, grazie a un’inedita ricetta, è adatto a preparazioni fredde e calde, per un utilizzo fantasioso in cucina;
- edelblu Cubes nell’innovativo pack 2x50 g che azzera gli sprechi.
Pratici e versatili, i cubetti da 6 mm sono perfetti per rendere appetitose insalate, pizze, gratin e ricette fredde o al forno;
- edelblu Gourmet nella vaschetta da 100 g.
Ricercato e versatile, è ottimo come ingrediente ma gustoso anche a freddo o per arricchire una selezione di formaggi.
www.bergader.it

Le i prodotti che se ne possono ricavare - integratori, nutraceutici, cosmetici - ha portato il dottor Pietro Rossi, perito chimico e laureato in farmacia, a realizzare un sogno, un’azienda di coltivazione e produzione. In portfolio oltre 250 p una pian 300 000 arborescens secondo trasformate


tti che se ne possono tegratori, nutraceutici, a portato il dottor perito chimico e farmacia, a realizzare un’azienda ivazione e In portfolio odotti e ione con te di aloe coltivate disciplinare n succhi
ed estratti subito dopo la raccolta, processate a freddo senza alterare gli equilibri dei vari componenti.
“Dopo la laurea aperto la prima parafarmacia d’Italia con annessa erboristeria - racconta Pietro Rossi, titolare di Energia delle Piante e Bio Botanicals - Ho proseguito con la formazione in omeopatia, iridologia e naturopatia ma avevo bisogno di andare oltre. Così ho acquistato una masseria in agro di Villa Castelli, periferia di



ed estratti subito dopo la raccolta, processate a freddo senza alterare gli equilibri dei vari componenti. “Dopo la laurea aperto la prima parafarmacia d’Italia con annessa erboristeria - racconta Pietro Rossi, titolare di Energia delle Piante e Bio Botanicals - Ho proseguito con la formazione in omeopatia, iridologia e naturopatia ma avevo bisogno di andare oltre. Così ho acquistato una masseria in agro di Villa Castelli, periferia di
Grottaglie (Taranto) trasformandola in un sito produttivo di 2.500 metri quadri L’incontro con Padre Romano Zago e la sua ricetta per l’aloe arborescens, come coadiuvante per i pazienti in cura per patologie oncologiche e radioterapiche, detossicante, tonico ed energetico in grado di ristabilire l’omeostasi dell’organismo”. Le piantagioni si sviluppano su circa 10 ettari di cui cinque in serra, e utilizzano l’energia pulita dei pannelli fotovoltaici. Una miniera d’oro “verde” per chi ha bisogno di ingredienti per le proprie produzioni, dal farmaceutico, integratori e cosmetici
o) trasformandola in un sito produttivo di 2.500 metri quadri L’incontro con Padre Romano Zago e la sua ricetta per l’aloe arborescens, come coadiuvante per i pazienti in cura per patologie oncologiche e radioterapiche, detossicante, tonico ed energetico in grado di ristabilire l’omeostasi dell’organismo”. Le piantagioni si sviluppano su circa 10 ettari di cui cinque in serra, e utilizzano l’energia pulita dei pannelli fotovoltaici. Una miniera d’oro “verde” per chi ha bisogno di ingredienti per le proprie produzioni, dal farmaceutico, integratori e cosmetici
Villa Castelli (BR) | tel. (+39) 099 9903001 ww w.energiadellepiante.com
Villa Castelli (BR) | tel. (+39) 099 9903001 ww w.energiadellepiante.com


LVERA SUCCO
ALOE VERA SUCCO CON MIRTILLO ROSSO da certi cazione biologica
e i prodott ricavare - integ cosmetici - ha
MIRTILLO ROSSO cazione biologica
Pietro Rossi, pe laureato in farm un sogno, un’azi di coltivazione produzione. In portf oltre 250 prod una piantagion 300 000 piante d arborescens coltivate secondo il disciplinare trasformate in succhi



Dalla passione di un pioniere nasce la piantagione di aloe arborescens di Energia delle Piante



a racc za alterare omponenti. la prima


ALOE VERA SUCCO PURO AL 100% da agricoltura biologica certi cata
ALOE VERA SUCCO PURO AL 100% da agricoltura biologica certi cata

ALOE ARBORESCENS RICETTA DI PADRE ROMANO ZAGO da agricoltura biologica certi cata
Pietro Rossi


ALOE ARBORESCENS RICETTA DI PADRE ROMANO ZAGO da agricoltura biologica certi cata

ome naturopatia ma avevo bisogno di andare oltre. Così ho acquistato una sseria in agro di a Castelli, periferia di
ottaglie (Taranto) trasformandola to produttivo di 2.500 metri L’incontro con Padre Romano ago e la sua ricetta per l’aloe arborescens, come coadiuvante per i pazienti in cura per patologie oncologiche e radioterapiche, cante, tonico ed energetico stabilire l’omeostasi o”. Le piantagioni si su circa 10 ettari di cui a, e utilizzano l’energia annelli fotovoltaici. ra d’oro “verde” per chi ha bisogno di ingredienti per le proprie produzioni, dal farmaceutico, integratori e cosmetici



Promoting good health through the use of organically grown herbs and natural substances is the mission of Energia delle Piante, a company known for its reliability, transparency, and the high quality of its raw materials. Organic farming follows the guidelines established by EU regulations (CE 834/07 and 889/08) and national law (Ministerial Decree 18354/09), minimizing the exploitation of natural resources in favor of sustainability. In organic farming, only natural substances such as plant-based fertilizers, natural nutrients, and carefully selected minerals can be used. These elements, when dispersed into the soil, help create and maintain a healthy environment for plant growth. The therapeutic power of active ingredients and phytocomplexes found in plants has long been scientifically recognized, and these natural compounds can be incorporated into the diet to support human well-being.
Energia delle Piante, led by Dr. Rossi and supported by a team of biotechnologists, biologists, and pharmacists, collaborates with university research centers to continuously develop natural ingredients aimed at enhancing health and well-being. The company’s flagship product is Aloe Arborescens preparation, based on the traditional recipe of Father Romano Zago. This formulation consists of acacia honey, freshly harvested Aloe Arborescens leaves, and distilled aloe. Aloe Arborescens belongs to the succulent Aloaceae family and is widely used both as an ornamental plant and as a medicinal plant with remarkable therapeutic properties.
Scientific studies have documented numerous health benefits of Aloe Arborescens, including its detoxifying properties, its role as an immune system booster and regulator, and its anti-inflammatory, analgesic, antiseptic, tissue-regenerating, wound-healing, antioxidant, and anti-aging effects. These characteristics make it a powerful natural

remedy for various health conditions, including severe illnesses. Over time, the company has expanded its product line to include other formulations featuring Aloe Vera.
“In addition, we apply the most innovative and eco-sustainable extraction technologies, such as ultrasound-based techniques, to obtain highly concentrated Full Spectrum extracts from a wide variety of plants,” explains the company. “In recent years, we have also expanded our production of liposomal extracts and supplements, which offer significantly higher bioavailability compared to traditional plant extracts.”
www.energiadellepiante.com


Favorire la buona salute con l’utilizzo di erbe da agricoltura biologica e sostanze naturali è l’obiettivo di Energia delle Piante, azienda che si distingue per affidabilità, trasparenza e qualità delle materie prime. L’agricoltura biologica è un modello produttivo disciplinato dai regolamenti Ce 834/07 e 889/08 e a livello nazionale con il decreto ministeriale 18354/09 che riduce al minimo lo sfruttamento delle risorse naturali in favore della sostenibilità.
Nelle coltivazioni biologiche è possibile utilizzare soltanto sostanze di origine naturale quali concimi vegetali, fertilizzanti naturali e minerali, opportunamente selezionati, che dispersi nel terreno contribuiscono a proteggere e creare un ambiente salutare per le piante.
Da molti anni è infatti scientificamente riconosciuto il potere terapeutico derivante dai principi attivi e/o fitocomplessi presenti nelle piante, principi che possono essere integrati nell’alimentazione per il benessere dell’uomo. L’Energia delle Piante diretta dal Dr. Rossi, coadiuvato da un team di biotecnologi, biologi, farmacisti e con l’aiuto di alcuni centri universitari, è costantemente impegnata nella ricerca e sviluppo di ingredienti naturali al fine di contribuire a migliorare la salute e il benessere per ogni esigenza dei clienti.
Il prodotto principale è il preparato di Aloe Arborescens con la ricetta classica di Padre Romano Zago, a base di miele di acacia, foglie fresche di Aloe Arborescens appena raccolte e distillato di aloe. L’Aloe Arborescens è una pianta succulenta della famiglia delle Aloacee, usata sia come pianta ornamentale, sia come pianta medicinale con virtù terapeutiche straordinarie. L’Aloe Arborescens ha moltissimi e documentati effetti benefici sulla salute come disintossicante, efficace stimolatore e regolatore del sistema immunitario, antinfiammatorio, analgesico, antisettico, stimolante della rigenerazione tissutale, cicatrizzante, antiossidante e antinvecchiamento, peculiarità che la rendono un potente rimedio per numerose patologie anche severe.

A questo preparato si sono aggiunti, nel tempo, altri prodotti a base anche di Aloe vera. «Applichiamo inoltre le più innovative tecnologie estrattive ed ecosostenibili (ultrasuoni) per ottenere estratti concentrati Full Spectrum da una vasta varietà di piante.
Negli ultimi anni abbiamo implementato la produzione di estratti e integratori Liposomiali con vantaggi di biodisponibilità molto superiori ai classici estratti vegetali.
www.energiadellepiante.com

Summer 2025 marks a strategic milestone for Birra Castello S.p.A., as the company chooses the liveliest season of the year to launch the rebranding of its Castello and Pedavena brands, while also strengthening the image of the Dolomiti brand through major mountain cycling events.
The Castello brand kicks off the season by renewing its partnership with the Italian Tennis and Padel Federation (FITP) through 2027, confirming its presence in the national Slam Padel by Mini circuit. The last two stops before the final Master tournament will take place in Desenzano del Garda (July 21–27) and Rome (September 8–14). A major new development is Castello’s debut in the tennis world: the brand will also feature at the BMW Serie A1 Finals, further expanding its exposure beyond the padel court.
In May, Castello played a starring role at the World Legends Padel Tour in Rome, where football legends took to the court, including Francesco Totti and Fernando Llorente. The latter, alongside Diego Perotti, won the stage. In June, the energy shifted to Sardinia with the Mini Padel Summer Tour at Forte Village in Cagliari—a perfect blend of sport, entertainment, and beer. And there’s more: Castello is gearing up for an exciting new summer challenge against Bombeer in a threestage tournament held at some of Italy’s most exclusive beach resorts (Jesolo, Lignano, and Cervia) between July 14 and 26, with a grand finale scheduled in Milan this September with the legends of Italian football.


BIRRA CASTELLO SPA: UN’ESTATE DI EVENTI, SPORT PER CASTELLO, PEDAVENA E DOLOMITI
L’estate 2025 segna una tappa strategica per Birra Castello S.p.A., che sceglie la stagione più vivace dell’anno per lanciare il rebranding dei marchi Castello e Pedavena, e per consolidare l’immagine del brand Dolomiti nei grandi eventi del ciclismo di montagna.
Il brand Castello apre la stagione con il rinnovo della partnership con la Federazione Italiana Tennis e Padel (FITP) fino al 2027, confermando la sua presenza nel circuito nazionale Slam Padel by Mini.
Le ultime tappe prima del Master finale saranno quelle di Desenzano del Garda (21-27 luglio) e Roma (8-14 settembre). Ma la vera novità è il debutto nel tennis: il marchio sarà presente alle Finali Serie A1 BMW, rafforzando così la sua esposizione anche fuori dal campo da padel.
A maggio, Castello è stata protagonista del World Legends Padel Tour a Roma, dove le leggende del calcio si sono sfidate in campo, tra cui Francesco Totti e Fernando Llorente. Quest’ultimo, insieme a Diego Perotti, ha conquistato la tappa. A giugno, l’energia si è spostata in Sardegna con il Mini Padel Summer Tour, al Forte Village di Cagliari, un mix perfetto di sport, spettacolo e birra.
beer
Meanwhile, the Pedavena brand will take center stage at the Sunset Jazz Festival in Sabaudia (July 11–27), an elegant and relaxed event that celebrates music at sundown. Pedavena is also renewing its bond with the Belluno region by sponsoring local sports and cultural events, such as the Palio di Feltre.
Lastly, Birra Dolomiti reaffirms its role as the official beer of the legendary Maratona dles Dolomites - Enel, set for July 6. This is a unique
opportunity to connect the authentic taste of Dolomiti with the passion for cycling and the stunning beauty of the Alps.
It’s a packed summer for Birra Castello S.p.A., which, through targeted events and strategic partnerships, continues to enhance the value of its brands and their deep connection with sport, culture, and the territory.
www.birracastellospa.it


Non finisce qui: Castello si prepara per un’inedita sfida estiva contro Bombeer in un torneo a tre tappe nei lidi più esclusivi d’Italia (Jesolo, Lignano e Cervia) tra il 14 e il 26 luglio, con una finalissima prevista a Milano a settembre.
Parallelamente, il brand Pedavena sarà protagonista del Sunset Jazz Festival a Sabaudia (11-27 luglio), un evento elegante e rilassato che celebra la musica al tramonto. Pedavena rinnova anche il suo legame con il territorio bellunese, sponsorizzando eventi sportivi e culturali, come il Palio di Feltre.
Infine, Birra Dolomiti si conferma come la birra ufficiale della leggendaria Maratona dles DolomitesEnel, in programma il 6 luglio. Un’occasione unica per legare il gusto autentico di Dolomiti alla passione per il ciclismo e alla bellezza delle Alpi.
Un’estate intensa per Birra Castello S.p.A., che con eventi mirati e partnership strategiche rafforza il valore dei suoi marchi e il loro legame con sport, cultura e territorio.
www.birracastellospa.it


































































































































































At Pastificio Cecchin, we believe that the secret to truly exceptional pasta lies in passion, precision, and a deep respect for culinary tradition.
For over 25 years, we have specialized in crafting authentic, artisan fresh pasta, inspired by classic recipes and prepared using only the finest, freshest ingredients.
Our pasta dough is made from a carefully balanced blend of durum wheat semolina, soft “0” wheat flour, and fresh eggs, selected for optimal texture, compactness, and authentic flavor. We prepare all fillings and sauces in-house using fresh meats, seasonal vegetables, and traditional methods that enhance natural aromas and taste.



From this commitment to quality and authenticity, we produce a wide range of handcrafted specialties designed to meet the demands of high-level food service professionals.
Artisan quality, modern standards
Our production facility integrates modern food technology with artisanal techniques, ensuring consistency, flavor integrity, and high production standards.
We are certified to the highest international benchmarks, including IFS, and operate in full compliance with HACCP, guaranteeing food safety, traceability, and reliability.
Product range for HoReCa:
• Fresh egg pasta
• Handmade Tortelloni
• Ravioli
• Cappelletti and fagottini
• Ready-to-eat crespelle with gourmet fillings (Heat and serve!)
• Potato and pumpkin gnocchi
Available formats:
• Fresh pasta: 500g and 1000g packs
• Gnocchi: 400g, 2000g, and 2500g packs
At Pastificio Cecchin, we bring Italian craftsmanship to the professional kitchen— offering chefs a product that combines tradition, quality, and convenience to enrich any menu.
www.pastacecchin.it


















by Céline Perez Director of Hostelco

As the hospitality industry undergoes rapid transformation, trade shows are becoming essential platforms to connect players, share knowledge and anticipate future trends. Within this context, Hostelco plays a pivotal role at Alimentaria + Hostelco 2026, bringing together hospitality, foodservice and retail to foster innovation, sustainability and internationalisation. On the occasion of Alimentaria’s 50th anniversary, we spoke with Céline Pérez to learn more about the strategic importance of this edition and the opportunities it will create for the horeca industry worldwide..
What role does Hostelco play within Alimentaria + Hostelco 2026 as a platform connecting the hospitality, foodservice and retail sectors?
Hostelco is the space where the hospitality industry meets innovation, design and technology.
Within Alimentaria + Hostelco 2026, it plays a pivotal role by bringing together all the key players of horeca and creating a natural bridge with the foodservice and retail sectors. This cross-cutting approach
ensures that equipment, technology, gastronomy and new business models are interconnected, allowing professionals to explore solutions that go far beyond their own industry and to discover synergies that make them more competitive and sustainable. In short, Hostelco amplifies the event’s capacity to generate value by showing how hospitality is an essential partner of the entire food chain.
How will the event address the key themes shaping the future of horeca, such as innovation, sustainability and internationalisation?
These three themes are at the heart of our next edition. Innovation will be present not only through cutting-edge equipment and digital solutions, but also with initiatives such as the Food & Hospitality Startups area, which will showcase disruptive proposals from entrepreneurs.
Sustainability, on the other hand, is now a nonnegotiable demand from consumers and businesses alike, and Hostelco will present solutions ranging from energy-efficient equipment to sustainable


interior design and eco-friendly catering models. Finally, internationalisation is one of our strongest pillars: we expect nearly a third of the exhibitors to come from outside Spain, Our mission is to enable professionals to close profitable and scalable deals, both domestically and internationally. Therefore, we have increased our investment to attract key buyers and expand the number of business meetings, thus consolidating our role as generators of real opportunities in an international environment.
In this edition, we hope to expand to more than 70 strategic countries, including Portugal, Germany, the United Kingdom, Poland, Mexico, the Netherlands, Morocco, Belgium, France, and the United States. We plan to facilitate more than 14,000 business meetings with international buyers, making the event a true gateway to global expansion.
How strategic are the synergies between the food and hospitality industries in responding to the main challenges of the sector and fostering new global business opportunities?
They are absolutely strategic. The hospitality sector cannot evolve without the food industry, and vice versa.
Today’s consumer wants an integrated experience: high-quality food, but also the right atmosphere, efficient service and responsible practices. By bringing both worlds together, Alimentaria + Hostelco creates the conditions for companies to co-create solutions, whether that means developing new concepts for restaurants,




embracing digitalisation, or promoting healthier and more sustainable food experiences. These synergies are also the key to addressing the sector’s global challenges: from supply chain resilience to workforce training and adapting to new consumer demands.
Our alliance facilitates the work of buyers, who find solutions ranging from food production to the most innovative equipment for the hospitality industry in a single space.
This complementarity allows us to approach the sector from all angles, creating a highly specialized space where supply and demand meet.
This edition marks Alimentaria’s 50th anniversary: what is the significance of this milestone and how does it reinforce the event’s position as an international benchmark?
Celebrating 50 years means celebrating half a century of leadership and service to the industry. Alimentaria has accompanied companies through profound transformations, and its longevity is proof of its relevance and capacity to adapt. For its part, the Hostelco brand was created in 1977, which reaffirms its consolidation in the trade fair market.
Being part of Alimentaria’s 50th anniversary: underlines our shared mission: to be not just a trade fair, but a true international benchmark for knowledge, networking and business generation. This milestone strengthens our role as a platform that shapes the future of food and hospitality, while honouring the history and achievements that brought us here.
Looking ahead to 2026, we’re building a new experience. This 2026 event will feature a revamped HORECA HUB under the motto “The Shift,” offering sessions on new ways of thinking and leading. The event will add new areas for Coffee and Bakery & Pastry, with a barista championship, a “Coffee Route,” and a “Future” hub exploring industry changes.
The “Collective Catering Meeting Point” will be expanded, and the Hostelco Awards will become the Horeca Awards with new categories.
From global competitiveness to the launch of new initiatives Alimentaria + Hostelco 2026 confirms its role as a benchmark event for the hospitality and food sectors.
With its strong international dimension and focus on the future of horeca, the event will once again serve as a meeting point where innovation, sustainability and business growth converge.
www.hostelco.com www.alimentaria.com

The Coralis Consortium – a small-scale organized distribution group – was founded to offer independent entrepreneurs the benefits of a modern retail network. After more than twenty years in operation, Coralis is opening a new and distinctive chapter with the launch of its private label collections: Verdeblu, Bontò, Todo, and Bontà Artigiana.
Bontò offers a selection of everyday food products carefully chosen to strike the right balance between quality and price.
Todo includes a wide range of essentials for home and personal care: cleaning products, paper goods, single-use items (strictly compostable), household articles, and personal hygiene products.


CORALIS PRESENTA VERDEBLU, BONTÒ, TODO E BONTÀ ARTIGIANA, COLLEZIONI DI PRODOTTI E DI VALORI

Il Consorzio Coralis - piccola distribuzione organizzata - nato per offrire anche a piccoli imprenditori indipendenti i vantaggi di una organizzazione distributiva moderna, dopo aver compiuto vent’anni, apre un nuovo e inedito capitolo con le sue col-
lezioni a marchio privato: VerdeBlu, Bontò, Todo e Bontà Artigiana.
Bontò è una selezione di prodotti alimentari per la spesa di tutti i giorni in cui si è pensato a una gamma di referenze in cui qualità e prezzo abbiano un giusto equilibrio; Todo, raccoglie tutto ciò che è essenziale per la cura della casa e della persona: detergenza, articoli di carta, ar-


Bontà Artigiana is a brand dedicated to festive occasions, featuring premium baked goods made with refined recipes and packaging designed to reflect the glamour of holiday celebrations.
Finally, Verdeblu is a curated collection of high-quality food products with strong regional roots. This line was made possible thanks to the active involvement of Coralis members who, with their in-depth knowledge of local areas and producers, have assembled a range that celebrates the tastes and excellence of their regions.
Verdeblu brings together gourmet items where artisanal techniques and refined recipes make the products true ambassadors of their territory, offering customers a premium experience.
While Bontò and Todo represent the core of the offer in economic terms, thanks to a price-quality-focused selection, Bontà Artigiana and Verdeblu are the collections that elevate the image of Coralis members’ stores to a higher-end positioning. From product quality and assortment depth to packaging and the communication campaigns that accompany both brands, everything tells the story of premium collections built on authenticity and care.
www.consorziocoralis.it

ticoli mono-uso, rigorosamente compostabili, articoli per la casa e tutto ciò che riguarda la cura e l’igiene della persona; Bontà Artigiana, è un brand dedicato alle ricorrenze: prodotti da forno di alta qualità con ricettazioni ricercate e con incarti studiati per restituire tutto il glamour delle feste; infine VerdeBlu è una collezione di prodotti alimentari di alta qualità con una forte appartenenza territoriale. Tutto ciò è stato possibile grazie alla partecipazione attiva dei soci Coralis che, da gran conoscitori dei propri territori di appartenenza e dei produttori locali, hanno creato un assortimento che racconta i gusti e le eccellenze della propria regione. VerdeBlu raccoglie gourmandise in cui l’alto livello delle lavorazioni e delle ricette con cui i prodotti sono realizzati rende i prodotti stessi ambassador del proprio territorio e offre una gamma premium ai clienti. Se Bontò e Todo sono sicuramente i più rilevanti da un punto di vista economico in quanto è stato studiato un paniere in cui il rapporto qualità-prezzo è centrale, Bontà Artigiana e VerdeBlu, a livello di immagine, sono sicuramente le collezioni che connotano le insegne dei nostri soci in una fascia alta di mercato: dalla qualità alla profondità di assortimento, dal pack alla campagna di comunicazione che accompagna questi due brand, tutto racconta una storia di prodotti Premium.
www.consorziocoralis.it



In the heart of Chiavenna, the Pastificio di Chiavenna began its journey in 1868 as a Mill and Pasta Factory. Guided by the Moro family’s passion and expertise, it has grown across five generations into a symbol of tradition and innovation. In the 1960s, the factory moved to a modern facility on the city’s edge, continuing to produce high-quality pasta.
Over time, the company became a European leader in the production of Pizzoccheri della Valtellina PGI, officially recognized with PGI status in 2016. Its offerings include pastas made from buckwheat, rye, and legumes-key ingredients of the local culinary identity. The factory also leads in the production of dietary and children’s pasta, in collaboration with renowned international brands.
The Pastificio was recently awarded the honorary status of “historic company” by the Chambers of Commerce, recognizing its role in preserving and passing down generations of entrepreneurial values and artisanal knowledge.
Today, tradition, health, and innovation come together in every product. The company carefully selects raw materials such as durum wheat, whole buckwheat, rye, and legumes to create pastas that are not only rich in fiber and nutrients but also full of authentic flavor. Ancient grains like buckwheat bring a unique touch to the table, blending rustic roots with modern taste.

OLTRE 150 ANNI DI GUSTO: TRADIZIONE E INNOVAZIONE NEL PIATTO
Nel cuore di Chiavenna, il Pastificio di Chiavenna ha iniziato il suo percorso nel 1868 come Mulino e Pastificio. Da allora, cinque generazioni della famiglia Moro hanno portato avanti un’eredità fatta di passione, qualità e capacità di innovarsi, trasformando il marchio in un simbolo della tradizione valtellinese. Negli anni ’60, l’azienda si è trasferita in una nuova sede alle porte della città, mantenendo intatto lo spirito artigianale.
Nel tempo, il Pastificio è diventato leader europeo nella produzione dei Pizzoccheri della Valtellina IGP e simbolo di un’identità culinaria che valorizza ingredienti come grano saraceno, segale e legumi. L’azienda è oggi un punto di riferimento anche per la produzione di paste dietetiche e per l’infanzia, collaborando con brand internazionali.
Il prestigioso riconoscimento di “impresa storica”, conferito dalle Camere di Commercio, ha premiato il valore imprenditoriale

bev food&

Its commitment to dietary and baby pasta reflects a long-standing focus on health and wellness. Certified by the Ministry of Health for dietary pasta production, the company employs 70 people and produces 10 million kg of pasta annually-40% of which is exported-generating €23 million in revenue. A portion of the energy used comes from certified green sources, such as the company’s own hydroelectric plants in Valtellina.
Among its most iconic products, the Pizzoccheri della Valtellina PGI represent a culinary tradition made known worldwide. The fusion of buckwheat and the pure water of the Alps creates a pasta that is not just food, but a real culinary experience, it is a story of passion, dedication, and respect for nature and local traditions.
More than just food, it’s a sensorial journey that brings the heritage and taste of the Valley to every dish.
Alongside buckwheat, rye plays a central role in the company’s production philosophy.
With its slightly spicy flavor and deep agricultural roots in Valtellina, rye, with its rich and slightly spiced taste, is a grain that has deep roots in the agricultural history of Valtellina.
Its flour, integrated into our production processes, gives the pasta a distinctive texture and flavor that reflects the genuineness of the territory.
Each product tells a story-of the land, the people, and a deep connection to nature and tradition.
It’s an invitation to savor authentic flavors and rediscover the culinary soul of Valchiavenna.
www.moropasta.it
Follow us on social media @moropasta



trasmesso nel tempo. Oggi il Pastificio di Chiavenna unisce tradizione e salute, creando paste nutrienti e gustose, fonte di fibre e realizzate con farine selezionate, come quella integrale di grano saraceno e la farina di segale. Con 70 dipendenti e una produzione annua di 10 milioni di kg di pasta, di cui il 40% destinato all’export, l’azienda nel 2024 ha raggiunto un fatturato di 23 milioni di euro. Un risultato ottenuto anche grazie all’uso di energia verde certificata, proveniente dalle centrali idroelettriche della Valtellina, e a un approccio produttivo attento alla salute e all’ambiente.
Tra i prodotti più rappresentativi, i Pizzoccheri della Valtellina IGP incarnano l’essenza della tradizione gastronomica locale, trasformandosi in ambasciatori del gusto italiano nel mondo. La fusione tra il grano saraceno e l’acqua pura delle Alpi crea una pasta che non è solo un alimento, ma una vera e propria esperienza culinaria: una storia di passione, dedizione e rispetto per la natura e le tradizioni locali. La sua texture ruvida la rende perfetta per assorbire i condimenti, offrendo un’esperienza sensoriale unica.
Accanto al grano saraceno, la segale occupa un posto speciale: con il suo gusto ricco e leggermente speziato, è un cereale che ha radici profonde nella storia agricola valtellinese. La sua farina, integrata nei nostri processi di produzione, dona alla pasta una texture inconfondibile e un sapore che rispecchia la genuinità del territorio. Ogni prodotto racconta una storia: quella della Valchiavenna, della sua gente e della sua cultura. Un patrimonio di valori che, ogni giorno, prende forma in una pasta capace di unire tradizione e innovazione, qualità e benessere.
www.moropasta.it seguici sui social @moropasta


Forgrana Corradini S.p.A., founded in 1850 and located between Parma and Reggio Emilia, has received an award as a historical Italian company. The ageing, storage and distribution of Parmigiano Reggiano and Grana Padano is the company’s core business, as well as the production of grated, fresh and dehydrated products, and the division of the cheeses into all portion sizes. In addition to selling in Italy, Forgrana exports its products to several European and non-European countries. We pay extra attention to quality, and our importers consider Italian excellence to be a value that must be preserved and spread.


FORGRANA PRESENTA IL PARMIGIANO REGGIANO DELLA LINEA “SUPER”
Forgrana Corradini S.p.A., nata nel 1850 e situata tra Parma e Reggio Emilia, è stata premiata come azienda storica italiana. Stagionatura, stoccaggio e distribuzione di Parmigiano Reggiano e Grana Padano sono il core business dell’azienda, insieme alla produzione di grattugiati, freschi e disidratati, e di porzionati in tutte le pezzature. Oltre al commercio nel Bel Paese, Forgrana esporta in vari paesi europei ed extra-europei. Siamo molto attenti alla ricerca della qualità, e gli importatori considerano l’eccellenza italiana un valore da preservare e diffondere.
Today, Forgrana is presenting its jewel in the crown: its “Super” range Parmigiano Reggiano. It is an extremely high-quality DOP product, available in various sizes. It is best consumed by cutting it with a knife and eating it as an aperitif together with a glass of good wine. This product is a delicacy enveloping all your senses wherever you are, in a small Italian square or at the top of a city skyscraper, providing a moment of pleasure and relaxation in this chaotic world we live in.
Our most important grated product is Fresco Più, a great, versatile mix, made with the aid of an innovative cleanroom. This technology provides a constant mix with excellent conditions of wholesomeness for this grated cheese with a much longer expiration date compared to similar products from other brands.
In this same production area, we have a soft, tasty fresh grated Parmigiano Reggiano, perfect for simple dishes, such as pasta with tomato and basil sauce, or the traditional Italian pasta dishes like pasta with pesto, lasagne, or tortellini in broth. The must-have ally in your kitchen.
With its monthly production capacity for these products of 100,000 Kg, Forgrana combines tradition and innovation, the source of great pride for the Corradini family who has been improving the level of the brand for decades.
www.forgranacorradini.it




Oggi Forgrana presenta un suo fiore all’occhiello: il Parmigiano Reggiano della linea “Super”. Si tratta di una DOP molto pregiata, disponibile in vari formati. La sua maggiore valorizzazione si ottiene tagliandolo con coltello e gustandolo come aperitivo insieme ad un calice di buon vino. In una tipica piazzetta italiana o in cima ad un grattacielo metropolitano, questo prodotto è una delizia che coinvolge tutti i sensi, regalando un momento di piacere e relax in questa società frenetica.
Tra i grattugiati, il nostro più significativo prodotto è il Fresco Più, un mix molto buono e versatile, realizzato con l’ausilio di un’innovativa camera bianca. Questa tecnologia permette una miscela costante e condizioni di salubrità ottimali per la produzione di un grattugiato con scadenza molto più lunga rispetto a prodotti analoghi di altre marche.
Sempre in quest’area produttiva, abbiamo un grattugiato fresco di Parmigiano Reggiano, soffice e gustoso, che valorizza sia piatti semplici, come la nostra pasta al pomodoro e basilico, che i grandi primi della tradizione italiana, come la pasta al pesto, le lasagne, i tortellini in brodo. Un alleato indispensabile in cucina.
Con una capacità produttiva mensile, per questi prodotti, di 100.000 kg, Forgrana coniuga tradizione e innovazione, motivo di grande orgoglio per la famiglia Corradini, che attraverso i decenni porta il brand a livelli sempre più alti.
www.forgranacorradini.it
It’s from that height that the path of 3 springs begins as they flow inside one of the most renowned Brescia mountains that frames the small medieval village of Bagolino. Thanks to its special hydrogeological conformation, Mount Maniva gives the water not only its name, but a number of unique characteristics such as purity, lightness and alkalinity as well as a pH value of 8 that makes it stand apart from most Italian waters.
In addition to this source from Mount Maniva in the Rhaetian Alps, Maniva Group has been the owner of the Verna mineral water since 2003. This water gushes out in a protected and uncontaminated location in the Tuscan province of Arezzo and precisely in the natural oasis of the Casentinesi Forests.
Founded in 1998, with a current workforce of over 60 employees spread across two production plants in Bagolino (in the Brescia province) and Chiusi della Verna (in Arezzo hinterland), a turnover of nearly 30 million euros and almost 200 million bottles produced, Maniva Spa is a successful and rapidly growing company in the crowded competitive landscape of the mineral water sector in Italy.
Maniva Group produces and trades 5 different brands of mineral water (i.e. Maniva, Balda, Verna, Classica and Vaia), a complete line of carbonated mineral water-based drinks and it also distributes Tomarchio branded soft

Da questa altezza inizia il percorso di 3 sorgenti che scorrono all’interno di una delle montagne bresciane più rinomate che fa da cornice al piccolo borgo medioevale di Bagolino.
Grazie alla sua speciale conformazione idrogeologica, il Monte Maniva conferisce all’acqua a cui dona il nome una serie di caratteristiche uniche: purezza, leggerezza e alcalinità, con valore del pH pari a 8 che la distingue dalla maggior parte delle acque italiane.
Oltre a questa sorgente delle Alpi Retiche, il Gruppo Maniva dal 2003 è proprietario dell’acqua minerale Verna, che sgorga in un luogo preservato ambientalmente e incontaminato in provincia di Arezzo, all’interno dell’Oasi naturale protetta delle Foreste Casentinesi.
Nata nel 1998, con un attuale organico di oltre 60 dipendenti dislocati nei due stabilimenti produttivi di Bagolino (provincia di Brescia) e Chiusi della Verna (entroterra aretino), un fatturato che sfiora i 30 milioni di euro e quasi 200 milioni di bottiglie prodotte, Maniva Spa è un’azienda solida e in rapida crescita nell’affollato panorama competitivo del settore dell’acqua minerale in Italia.
Il Gruppo Maniva produce e commercializza 5 marchi diversi di acqua minerale (Maniva, Balda, Verna, Classica e Vaia), oltre a



drinks. In addition to the trendy “SmileBox Maniva pH8” - the new sustainable packaging designed to preserve and maintain the organoleptic characteristics and alkaline benefits of pH8 Maniva mineral water unaltered - among the latest product innovations designed by the Brescia-based company, we have MINERAL SELTZ Maniva, the first mineral carbonated water in latest-generation kegs that preserve the organoleptic quality of Maniva mineral water and guarantee its purity, quality and carbonation down to the last drop, ideal for meeting the different blending needs of the beverage industry.
www.maniva.it

una linea completa di bibite gassate a base di acqua minerale e alla distribuzione delle bibite a marchio Tomarchio. Oltre all’attualissimo “Smile-Box Maniva pH8”- il nuovo packaging sostenibile studiato per preservare e mantenere inalterate le caratteristiche organolettiche e i benefici alcalini di Acqua Minerale Maniva pH8 - fra le ultime innovazioni di prodotto progettate dall’azienda bresciana è degna di nota la MINERAL SELTZ Maniva, prima acqua di seltz minerale in fusti, con tutta la garanzia di qualità organolettica dell’acqua minerale Maniva fornita in fusti di ultima generazione che garantiscono la purezza, la qualità e la gassatura dell’acqua fino all’ultima goccia, ideale per il vasto mondo della miscelazione nel mondo del fuoricasa.
www.maniva.it


Abbiamo bisogno di poche cose essenziali per vivere bene e a lungo: mangiare cibi sani e bere acqua minerale, meglio se di montagna, meglio se alcalina , a casa, al ristorante e all’aria aperta, magari camminando in un parco otra i boschi.


Maniva mette l’acqua del monte di cui porta il nome in contenitori riciclabili di VETRO, PET, R-PET, CARTA , per arrivare nel modo più sostenibile possibile a tutte le persone che desiderano il bene del pianeta quanto il loro. NON SPRECARE, RICICLA. È PER IL BENE DEL NOSTRO PIANETA.

On the occasion of its event on January 14-15, 2026, Marca by Bologna Fiere & ADM will launch the new Marca Awards, designed to recognize excellence in the Private Label supply chain.
This initiative, in collaboration with PL Magazine and with the support of IPLC, introduces for the first time an integrated ecosystem that values both product innovation and the industrial excellence of manufacturing companies. The goal is to reinforce the event’s role as a trendsetter for the Private Label sector.
The awards will be at the heart of the Marca Trend Area, an integrated space within the Bologna exhibition centre where visitors can get updated on the latest news and trends. With a single application form, companies will have the opportunity to compete for two complementary awards that enhance the entire value chain of the PL sector.

MARCA AWARDS 2026: I NUOVI
RICONOSCIMENTI PER L’ECCELLENZA
DELLA MARCA DEL DISTRIBUTORE
In occasione dell’edizione del 14 e 15 gennaio 2026, Marca by Bologna Fiere & ADM presenterà i nuovi Marca Awards, riconoscimenti ideati per celebrare l’eccellenza nella filiera della Marca del Distributore (MDD).
Questa iniziativa, sviluppata in collaborazione con PL Magazine e con il supporto di IPLC, introduce per la prima volta un ecosistema integrato che valorizza sia l’innovazione di prodotto sia l’eccellenza industriale dei produttori.
L’obiettivo è rafforzare il ruolo della manifestazione come punto di riferimento per la Distribuzione Moderna Organizzata.
I premi saranno al centro della Marca Trend Area, uno spazio dinamico all’interno del quartiere fieristico di Bologna, pensato per aggiornare i visitatori sulle tendenze e

bev food


The first award is the Best Innovation Product (formerly IPLS), dedicated to the most innovative private label products. It is divided into five categories representing the main areas of development: Sustainability; Food well-being (including pet food); Indoor & outdoor non-food well-being; Origin, provenance, supply chain and transparency; and Packaging.
The second recognition is the Best Copacker Profile, which awards the industrial excellence and reliability of manufacturing partners. This award covers nine categories across the entire range of Private Label products: groceries, beverages, fresh product, frozen foods, home care, personal care, pet care, other non-food products, and packaging.
The new format expands the outlook on the sector’s future, introducing a specific category for packaging to highlight its crucial role. This initiative offers the market a unique tool for identifying the product innovations and partners that help define trends in Private Label.
The award ceremony will be held on January 14, 2026, from 6:00 pm to 7:30 pm at the Marca Fair. For more information on how to participate, interested companies can visit the official website of Marca by BolognaFiere & ADM.
www.marcabybolognafiere.com
le novità del settore. Con un’unica candidatura, le aziende potranno concorrere per due riconoscimenti complementari che coprono l’intera catena del valore MDD.
Il primo premio è il Best Innovation Product, che sostituisce il precedente IPLS, dedicato ai prodotti MDD più innovativi. È articolato in cinque categorie: Sostenibilità; Benessere alimentare (incluso petfood); Benessere non alimentare indoor & outdoor; Origine, provenienza, filiera e trasparenza; e Packaging.
Il secondo riconoscimento è il Best Copacker Profile, che premia l’eccellenza e l’affidabilità dei partner produttivi. Questo premio si suddivide in nove categorie merceologiche: Drogheria alimentare, Bevande, Fresco, Freddo, Cura casa, Cura persona, Petcare, Altri prodotti non food e Packaging.
La nuova formula dei Marca Awards amplia la prospettiva sul futuro del settore, introducendo una categoria specifica per il packaging e fornendo a retailer e buyer uno strumento concreto per anticipare le tendenze.
Questa iniziativa offre al mercato un mezzo unico per individuare le innovazioni e i partner industriali che guidano lo sviluppo della MDD.
La cerimonia di premiazione si svolgerà il 14 gennaio 2026, dalle 18:00 alle 19:30, presso la Fiera Marca.
Per maggiori informazioni su come partecipare, le aziende possono consultare il sito ufficiale della manifestazione.
www.marcabybolognafiere.com









Masiello Food has an in-house Quality Control Laboratory equipped with precise and certified instruments aimed at ensuring food safety and consumer health by closely monitoring the key phases of the production process.
Dr. Arianna Rita Cristiano, Head of the Quality Laboratory, carries out constant internal checks to monitor fundamental parameters in the vegetable preserves sector, minimizing potential chemical, physical, and microbiological risks.
Every day, the internal analytical plan includes chemical and organoleptic analyses on raw materials ready for use and on the fi-

IL LABORATORIO INTERNO AZIENDALE: IL CUORE DEL CONTROLLO QUALITÀ E DELLA SICUREZZA ALIMENTARE
L’azienda Masiello Food dispone di un Laboratorio Controllo Qualità attrezzato di una strumentazione accurata e qualificata, che mira a garantire la sicurezza alimentare e la salute del consumatore tenendo sotto controllo le principali fasi del processo produttivo.
La Dott.ssa Arianna Rita Cristiano, Responsabile del Laboratorio qualità, effettua costantemente verifiche interne capaci di monitorare parametri fondamentali per il mondo delle conserve vegetali per ridurre al minimo i potenziali pericoli chimici, fisici e microbiologici.
Ogni giorno, infatti, il piano analitico interno prevede delle analisi chimiche e organolettiche da effettuare sulla materia prima pronta


nal product to ensure compliance with international standards before it is released for distribution. The laboratory is also a hub of new ideas and projects. Inside, a dedicated research and development team is constantly at work.
Through tastings, the development of new recipes, trials, and experiments, we create innovative products designed to appeal to demanding and attentive consumers.
Examples include the Pizzamood, Terrecrude, and Pomodoro Pugliese lines. What will be our next innovation?
www.masiellofood.com
per essere utilizzata e sul prodotto finito ottenuto per essere certi che il prodotto sia conforme agli standard internazionali e, quindi, avviarlo alla distribuzione.
Il laboratorio è anche il fulcro di nuove idee e progetti. All’interno, infatti, è presente un gruppo di ricerca e sviluppo sempre e costantemente in fermento.
Attraverso assaggi, elaborazione di nuove ricette, prove, esperimenti, infatti, riusciamo a dare vita a delle novità che possano attirare l’attenzione di una fascia di consumatori esigenti ed attenti: le linee Pizzamood, Terrecrude, Pomodoro Pugliese sono degli esempi. Quale sarà la prossima novità?
www.masiellofood.com

IT’S NOT ABOUT BEING PERFECT, BUT ABOUT WHAT YOU’RE MADE OF
The iconic biscuit from Gruppo Colussi becomes a limited edition, unique and with a powerful social message.
After the success of the brand repositioning carried out with DUDE in recent months, GranTurchese raises the message of uniqueness to a new level with BiscoRotti: a limited-edition line of biscuits conceived by DUDE and made from production waste. Biscuits already broken at the start, yet just as good and valuable as whole ones: a simple and powerful message that makes them true ambassadors of an inclusive approach.
If in previous campaigns the brand spoke about the uniqueness of each of us, making every breakfast and snack unique, today the aim is to highlight the uniqueness of its own biscuits by putting them on the same level as people. With BiscoRotti, the brand gets closer to the public to show that being different is not a limitation, but an added value.
The idea of this particular biscuit is launched with an equally unique campaign – or rather, an Imperfect Campaign. An ATL activity using billboards, wild posting, and standard outdoor spaces, flipping the usual format logic. The campaign includes multiple subjects, rolling out in September across different cities, where the creatives appear crooked, broken, upside down: in a word, imperfect.

GRANTURCHESE, INSIEME A DUDE, PRESENTA
BISCOROTTI: NON CONTA ESSERE PERFETTI, MA DI CHE PASTA SEI FATTO
L’iconico biscotto del Gruppo Colussi diventa un’edizione limitata, unica e con un messaggio dal forte valore sociale.
Dopo il successo del riposizionamento del brand, realizzato insieme a DUDE nei mesi scorsi, GranTurchese eleva il messaggio di unicità e lo porta a un nuovo livello con BiscoRotti: una limited edition di biscotti ideata da DUDE e ottenuta da scarti di produzione.
Biscotti già rotti in partenza, ma buoni e preziosi quanto quelli interi: un messaggio semplice e po-

tente che li rende veri ambasciatori di un approccio inclusivo.
Se negli spot precedenti il brand ha parlato dell’unicità di ognuno di noi, che rende ogni colazione e merenda unica, oggi l’obiettivo è quello di mettere in luce l’unicità dei propri biscotti ponendoli sullo stesso piano delle persone. Con BiscoRotti, il brand si avvicina al pubblico per dimostrare che essere differenti non è un limite, ma un valore aggiunto.
L’idea di questo particolare biscotto viene presentata con una campagna di lancio altrettanto unica, o meglio, una Imperfect Campaign. Un’attività ATL che utilizza billboard, wild posting e spazi affissione canonici, ribaltando la logica di formato.
Una campagna che prevede più soggetti in uscita

The goal is to transform imperfection into uniqueness and a source of pride, just like the BiscoRotti themselves.
This work was created hand in hand by the teams of Dude Milano and Dude Design, who “broke” and evolved GranTurchese’s visual codes towards a freer, more unconventional imagery.
The billboards are just the beginning of a 360° campaign by the brand, involving multiple media and platforms: GranTurchese will bring BiscoRotti directly to the streets of Milan, Bari and Naples with sampling sessions and merchandising in collaboration with Omnishopper, an omnichannel marketing agency.
This will be followed by specific activations on social networks – particularly TikTok – as well as an interactive landing page that tells the story of the project and the social values behind it.
From BiscoRotti also come three neon signs, created in collaboration with Insulti Luminosi: for one week, the brand’s “outlet” section — dedicated to signs with small flaws — will be fully branded BiscoRotti.
a settembre in diverse città, in cui le creatività si presentano storte, fatte a pezzi, al contrario: in una parola, Imperfette.
Per trasformare l’imperfezione in unicità e motivo di orgoglio, proprio come fanno gli stessi BiscoRotti.
Un lavoro fatto a quattro mani tra il team di Dude Milano e Dude Design, che ha “rotto” ed evoluto i codici visivi di GranTurchese verso un immaginario più libero e fuori dalle righe.
Le affissioni sono solo l’inizio di una campagna a 360° da parte del brand, che coinvolge media differenti e piattaforme trasversali: GranTurchese porterà infatti i BiscoRotti direttamente nelle strade di Milano, Bari e Napoli con sessioni di sampling e merchandising insieme a Omnishopper, agenzia di omnichannel marketing.
A seguire ci saranno delle specifiche attivazioni sui social network – in particolare su Tik Tok – oltre ad una landing page interattiva che racconta la genesi del progetto e i valori sociali che lo sostengono. Da BiscoRotti nascono anche tre insegne luminose, realizzate in collaborazione con Insulti Luminosi: per una settimana, la sezione “outlet” del brand

Francesco Meschieri, Marketing Director, Gruppo Colussi, commented:
“With BiscoRotti we want to value and celebrate the imperfections that make us unique: broken, chipped biscuits, different in shape but perfect in taste, just like each one of us. Thanks to DUDE’s help, we’ve created a campaign that – just like the biscuits themselves – is a true invitation to show our flaws: it’s our imperfection that makes us truly unique, capable of leaving a mark where standards fall short. With humor, sincerity, and a touch of self-irony, we want to celebrate those who, like us, don’t fit into the usual molds but turn every difference into strength.”
“The broken biscuits at the bottom of the package have always stirred tenderness. Today we’re proud to put them center stage, precisely because they’re broken, unique, imperfect. A project that speaks of authenticity, responsibility, identity and courage – just like the brand that made it possible: GranTurchese.” commented Lorenzo Foffani, Chief Strategy and Innovation Officer, DUDE.
www.granturchese.it
— dedicata alle insegne con piccoli difetti — sarà interamente brandizzata BiscoRotti.
Francesco Meschieri, Direttore Marketing, Gruppo Colussi commenta:
“Con BiscoRotti vogliamo valorizzare e celebrare le imperfezioni che ci rendono unici: biscotti spezzati, scheggiati, diversi per forma ma perfetti nel gusto, proprio come ognuno di noi. Grazie all’aiuto di Dude, abbiamo creato una campagna che – così come i biscotti stessi – è un vero e proprio invito a mostrare i propri difetti: è la nostra imperfezione a renderci davvero unici, capaci di lasciare il segno dove gli standard non arrivano. Con ironia, sincerità e un pizzico di autoironia, vogliamo celebrare chi, come noi, non si incastra nei soliti stampi, ma trasforma ogni diversità in forza.”
“I biscotti rotti in fondo alla confezione ci hanno sempre fatto tenerezza. Oggi siamo felici di metterli al centro, proprio perché spezzati, unici, rotti. Un progetto che parla di autenticità, responsabilità, identità e coraggio, proprio come il brand che l’ha reso possibile: GranTurchese.” ha commentato Lorenzo Foffani, Chief Strategy and Innovation Officer, DUDE.
www.granturchese.it

known for the variety and quality of its designed to meet specific culinary needs, from makers to home cooks. The Agricola Line, from sustainable farming, offers a healthy, Fruttarine, innovative flours with real for sweet and savoury recipes; the pizza soft, fragrant doughs; while Formato 12.5 for pizzerias and restaurants wanting flours are used in a wide range of artisan bakeries to large-scale maintaining the highest quality ensuring excellent results for professionals of the company led to the creation of where passion for food meets just a café, but a restaurant offering with ingredients from the company’s own Bertolo’s spacious, well-stocked shop of tradition where visitors can taste Molino Bertolo flours and a selection of enjoy at home.
Since 1742, the Bertolo family has been a benchmark in the milling sector, with a tradition handed down through five generations. Thanks to the dedication and expertise of its millers, the company has built a leading position in the Italian flour market. Molino Bertolo stands out for its commitment to combining traditional craftsmanship with modern technologies, offering products capable of satisfying even the most demanding palates, both at home and in professional kitchens.
Since 1742, the Bertolo family has been a benchmark in the milling sector, with a tradition handed down through five generations. Thanks to the dedication and expertise of its millers, the company has built a leading position in the Italian flour market. Molino Bertolo stands out for its commitment to combining traditional craftsmanship with modern technologies, offering products capable of satisfying even the most demanding palates, both at home and in professional kitchens.
Molino Bertolo’s mission is clear: every product is the result of a careful production process that combines centuries of experience with innovation. The quality of the flours is ensured by strict control of raw materials, selected from trusted grain suppliers, and by processing that respects traditional methods while using advanced solutions to improve each production phase, with full respect for the environment.
Molino Bertolo’s mission is clear: every product is the result of a careful production process that combines centuries of experience with innovation. The quality of the flours is ensured by strict control of raw materials, selected from trusted grain suppliers, and by processing that respects traditional methods while using advanced solutions to improve each production phase, with full respect for the environment.
Molino Bertolo is known for the variety and quality of its flours, each designed to meet specific culinary needs, from bakers and pizza makers to home cooks. The Agricola Line, made with grains from sustainable farming, offers a healthy, natural product; the Fruttarine, innovative flours with real dried fruit, are ideal for sweet and savoury recipes; the pizza flours help create soft, fragrant doughs; while Formato 12.5 is a versatile choice for pizzerias and restaurants wanting high-quality results.
Since 1742, the Bertolo family has been a benchmark in the milling sector, with a tradition handed down through five generations. Thanks to the dedication and expertise of its millers, the company has built a leading position in the Italian flour market. Molino Bertolo stands out for its commitment to combining traditional craftsmanship with modern technologies, offering products capable of satisfying even the most demanding palates, both at home and in professional kitchens.


Molino Bertolo is known for the variety and quality of its flours, each designed to meet specific culinary needs, from bakers and pizza makers to home cooks. The Agricola Line, made with grains from sustainable farming, offers a healthy, natural product; the Fruttarine, innovative flours with real dried fruit, are ideal for sweet and savoury recipes; the pizza flours help create soft, fragrant doughs; while Formato 12.5 is a versatile choice for pizzerias and restaurants wanting high-quality results.
All Molino Bertolo flours are used in a wide range of contexts, from small artisan bakeries to large-scale distribution, always maintaining the highest quality standards and ensuring excellent results for professionals and food lovers alike.
The steady growth of the company led to the creation of Casa Bertolo, a place where passion for food meets hospitality. It is not just a café, but a restaurant offering fresh dishes made with ingredients from the company’s own production. Casa Bertolo’s spacious, well-stocked shop represents a corner of tradition where visitors can taste products and buy Molino Bertolo flours and a selection of Italian specialties to enjoy at home.
All Molino Bertolo flours are used in a wide range of contexts, from small artisan bakeries to large-scale distribution, always maintaining the highest quality standards and ensuring excellent results for professionals and food lovers alike.
Molino Bertolo’s mission is clear: every product is the result of a careful production process that combines centuries of experience with innovation. The quality of the flours is ensured by strict control of raw materials, selected from trusted grain suppliers, and by processing that respects traditional methods while using advanced solutions to improve each production phase, with full respect for the environment.


Molino Bertolo’s range led to the creation where the finest flours are turned into pasta. The selection includes sheets, gnocchi, tortellini, ravioli and other classic exclusive “Pasta Your Way” service, create their ideal pasta by choosing from and shapes, for a product that reflects
The expansion of Molino Bertolo’s range led to the creation of Pastificio Bertolo, where the finest flours are turned into high-quality fresh pasta. The selection includes sheets, extruded shapes, gnocchi, tortellini, ravioli and other classic formats. With the exclusive “Pasta Your Way” service, customers can create their ideal pasta by choosing from different ingredients and shapes, for a product that reflects personal tastes and traditions. This custom approach
Molino Bertolo is known for the variety and quality of its flours, each designed to meet specific culinary needs, from bakers and pizza makers to home cooks. The Agricola Line, made with grains from sustainable farming, offers a healthy,



















The steady growth of the company led to the creation of Casa Bertolo, a place



visitors can taste products and buy Molino Bertolo flours and a selection of Italian


The expansion of Molino Bertolo’s range led to the creation of Pastificio Bertolo, where the finest flours are turned into high-quality fresh pasta. The selection in cludes sheets, extruded shapes, gnocchi,



tortellini, ravioli and other classic formats. With the exclusive “Pasta Your Way” service, customers can create their ideal pasta by choosing from different ingredients and shapes, for a product that reflects personal tastes and traditions.
This custom approach makes each step unique, from grain selection to the final filling, always focusing on quality and authenticity.
The Future of Molino Bertolo: Sustainability and Innovation Molino Bertolo keeps evolving while staying true to its values of quality and tradition. The company looks ahead
with a commitment to offer products that respect the environment, support the local area and meet the expectations of those who love good food.
The future path focuses on sustainability, with special care for responsible farming, waste reduction and the constant improvement of production processes. Innovation, respect for people and passion for quality will continue to guide Molino Bertolo for generations to come, bringing genuine, wholesome pro- ducts to tables all over the world.
molinobertolo.it pastificiobertolo.it


Born from the warmth of the sun and nurtured by the embrace of mother earth, Desantis olive oil captures the essence of a tradition passed down through generations. Founded in the 1950s by Giovanni Desantis in the heart of Puglia, the company has evolved from a small family-run mill into a cutting-edge enterprise, all while preserving its deep-rooted love for quality and the land.
Every drop of our extra virgin olive oil delivers the authentic taste of the Puglian region, infused with the unique aromas of its centuries-old olive groves. Hand-picked and cold-pressed, our olives retain their nutrients, offering both flavor and wellness in every dish.
We are the custodians of a tradition renewed daily, driven by a commitment to bring the essence of our land into homes worldwide. Skilled hands transform nature’s fruits into an unmatched oil that tells the story of Puglia.

OLIO DESANTIS: IL TUO OLIO QUOTIDIANO PER UNA VITA SANA E GUSTOSA
Nato dal calore del sole e nutrito dalla terra madre, l’olio Desantis rappresenta l’essenza di una tradizione che attraversa le generazioni. Fondato negli anni ‘50 da Giovanni Desantis nel cuore della Puglia, l’azienda ha trasformato un piccolo frantoio familiare in una realtà all’avanguardia, senza mai perdere l’amore per la qualità e il territorio.
Ogni goccia del nostro olio extravergine racchiude il sapore autentico del territorio pugliese e i profumi unici dei suoi uliveti secolari. Le olive, raccolte a mano e spremute a freddo, conservano intatte le proprietà nutritive, offrendo gusto e benessere in ogni piatto.
Siamo custodi di una tradizione che si rinnova ogni giorno. Il nostro impegno è portare nelle case l’essenza della nostra terra, grazie a mani esperte che trasformano i frutti della natura in un olio dal sapore ineguagliabile.


Desantis olive oil is more than a seasoning; it’s a lifestyle that celebrates the genuineness of Mediterranean cuisine. From bruschetta to gourmet creations, it enhances flavors and adds authenticity to every recipe.
Our belief in sustainability drives us to protect the environment for future generations. Through eco-friendly farming practices and innovative production techniques, we minimize environmental impact while ensuring exceptional quality at every stage.
With its breathtaking landscapes and mild climate, Puglia offers ideal conditions for cultivating olives, creating a perfect harmony between tradition and innovation.
We invite you to experience the difference Desantis olive oil brings to everyday cooking. Dress a fresh salad, prepare a savory sauce, or simply drizzle it over a slice of bread – quality is evident in every taste.
www.oliodesantis.it



L’olio Desantis non è solo un condimento, ma uno stile di vita che celebra la genuinità della cucina mediterranea. Dalla bruschetta ai piatti più elaborati, esalta i sapori e regala autenticità ad ogni ricetta.
Crediamo nella sostenibilità e proteggiamo l’ambiente per le future generazioni. Utilizziamo pratiche agricole rispettose e tecniche di produzione innovative per ridurre l’impatto ambientale, garantendo qualità in ogni fase produttiva.
La Puglia, con i suoi paesaggi mozzafiato e il clima mite, offre condizioni ideali per coltivare ulivi che creano un legame tra tradizione e innovazione.
Invitiamo tutti a scoprire la differenza che l’olio Desantis può fare nella cucina quotidiana. Condisci un’insalata fresca, prepara un sugo saporito o gusta una fetta di pane con un filo d’olio: la qualità si sente ad ogni assaggio.
www.oliodesantis.it

From Mario Fongo’s oven, where the legendary Lingue di Suocera were born in 1993, ideas are churned out that make the world of snacks “crunchy”. With selected flours and extra virgin olive oil, the Piedmontese company transforms bread-making into a creative ritual for those who demand taste, lightness and practicality.
If the long sheets of dough have made history, today the proposal is available in “bite-andrun” formats, ideal for aperitifs, office and travel. They are sold in flavour-saving packs ready to follow you everywhere. Here are the Mini Lingue: same iconic recipe, but in pocket-sized to crunch on their own or with hummus, tapenade and cheeses.

DALLE LINGUE DI SUOCERA AI PAN D’ARIA:
LA RIVOLUZIONE DELLO SNACK SECONDO
MARIO FONGO
Dal forno di Mario Fongo, dove nel 1993 nacquero le mitiche Lingue di Suocera, si sfornano idee che fanno “croccare” il mondo dello snack. Forte di farine selezionate ed olio extravergine d’oliva, l’azienda piemontese trasforma la panificazione in un rito creativo per chi chiede gusto, leggerezza e praticità.
Se le lunghe sfoglie hanno fatto storia, oggi la proposta si declina in formati “mordi e fuggi” ideali per aperitivi, ufficio e viaggio. Sono venduti in pack salva gusto pronti a seguirti ovunque. Ecco le Mini Lingue: stessa ricetta iconica, ma in dimensioni tascabili da sgranocchiare al naturale o con hummus, tapenade e formaggi. Accanto a loro brillano i Mini Rubatà, micro grissini che concentrano quattro secoli di tradizione torinese in pochi centimetri di pura croccantezza, perfetti con birre e cocktail.
Ultimo colpo di genio è il Pan d’Aria: soffici nuvole di pane, leggere come un respiro eppure saporite grazie a lunga lievitazione e cottura in forno che ne sigilla l’aroma. Uno snack leggero che strizza l’occhio a chi vuole un crunch senza sensi di colpa, ma versatile e capace di impreziosire ogni tavola.
Dietro a ogni prodotto c’è la famiglia Fongo: Mario, il figlio Giovanni e la moglie Marta che seguono impasto, cottura e confezionamento, coniugando automazione e cura artigianale. Così, tra lingue, bastoncini e nuvole, il marchio continua a raccontare il meglio del made in Italy, dimostrando che il futuro dello snack può nascere da una semplice idea di pane. Sì!
www.mariofongo.com

Alongside them shine the Pan d’Aria, micro breadsticks that concentrate four centuries of Turin tradition in a few centimetres of pure crunchiness, perfect with beers and cocktails.
The last stroke of genius is the Pan d’Aria: soft clouds of bread, light as a breath yet tasty thanks to the long leavening and baking in the oven that seals in the aroma.
A light snack that winks at those who want a crunch without sense of guilt, but versatile and capable of embellishing any table.
Behind every product there is the Fongo family: Mario, his son Giovanni and his wife Marta who follow the dough, cooking and packaging, combining automation and artisanal care.
Thus, between tongues, sticks and clouds, the brand continues to tell the best of Made in Italy, demonstrating that the future of snacks can be born from a simple idea.
www.mariofongo.com





Piuma d’Oro has been for sixty years the point of reference in the market of sweet snacks and fries, with the market share that overcomes 85% in Italy and is always more consolidated abroad.
A family run business has grown up in the name of quality and craftsmanship and has been able to transform the pastry tradition into a modern and recognizable experience, by conquering the trust of the Large -Scale Retail Trade, of the Ho.Re. Ca. channel, of the wholesalers and of the operators of the pastry industry.
The heart of Piuma d’Oro production is the 35.000 m² manufacturing plant - able to churn out up to 50.000 kg of snacks a day - an efficient organization based on a solid team of employees and temporary workers. Piuma d’Oro is endowed with business knowledge that is handed down every day and guarantees consistency, control and quality along all the production chain.
The flagship of the company lies in “chiacchiere di Carnevale”- Mardi Gras fritters: fragrant, light and aromatic, produced according to the traditional recipes. An accurate selection of the ingredients together with meticulous control in each production cycle ensures elevated standards and a quality that satisfies the most demanding tastes.


DOVE IL GUSTO DELLA TRADIZIONE INCONTRA IL FUTURO
Da oltre sessant’anni, Piuma d’Oro è un punto di riferimento nel mercato degli snack dolci e fritti, con una quota di mercato che in Italia supera l’85% e una presenza sempre più consolidata anche all’estero.
L’azienda – a conduzione familiare - è cresciuta nel segno della qualità e dell’artigianalità e ha saputo trasformare la tradizione pasticcera in un’esperienza moderna e riconoscibile, conquistando la fiducia della GDO, del canale Ho.Re.Ca., dei grossisti e degli operatori del comparto dolciario.

In 2025, the company decides to look ahead and expand its commercial offer with Lunelle: a new line of salted, circular, browned and crispy snacks, conceived for the annual distribution and made with natural and high-quality ingredients.
The name recalls the lunar texture of the surface while the elegant and functional layout adapts perfectly to the new moments of consumption.
An innovative proposal that combines delicacy and lightness, designed to capture the demands of an always more dynamic and variegated market.
With Lunelle, Piuma d’Oro confirms to be a trustworthy partner, a solid company rooted to the territory, able to innovate with vision, concreteness and value.
www.piumadoro.com



Il cuore produttivo di Piuma d’Oro è uno stabilimento di 35.000 m², capace di sfornare fino a 50.000 kg di snack al giorno: un’organizzazione efficiente che si regge su un solido nucleo di collaboratori fissi e stagionali. In Piuma d’Oro il sapere aziendale si tramanda ogni giorno e garantisce costanza, controllo e qualità lungo tutta la filiera.
Il fiore all’occhiello dell’azienda sono le chiacchiere di Carnevale: fragranti, leggere e profumate, sono prodotte nel rispetto delle ricette tradizionali.
La meticolosa selezione delle materie prime, unita a rigorosi controlli in ogni fase produttiva, assicura standard elevati e una qualità capace di soddisfare anche i palati più esigenti.
Nel 2025, l’azienda decide di guardare al futuro ampliando la sua offerta con le Lunelle: una nuova linea di snack salati, tondi, dorati e friabili, pensata per una distribuzione annuale e realizzata con ingredienti naturali e di alta qualità. Il nome richiama la texture “lunare” della superficie, mentre il formato – elegante e pratico – si adatta perfettamente a nuovi momenti di consumo.
Una proposta innovativa che coniuga golosità e leggerezza, pensata per intercettare le richieste di un mercato sempre più dinamico e diversificato.
Con Lunelle, Piuma d’Oro conferma la propria natura di partner affidabile: un’azienda solida, radicata nel territorio, capace di innovare con visione, concretezza e valore.
www.piumadoro.com

Over the years, SP SPA has been able to anticipate market trends, becoming a producer of ex-cellence in the rice sector. Its commitment to responding to challenges and seizing opportuni-ties has led the company to gain the trust of important brands on the international food scene. With the introduction of new product lines, SP SPA has embarked on a path towards sustain-ability, collaborating with local partners and promoting the cultivation and culture of rice. Stroppiana’s technologically advanced and fully automated processing plants give the com-pany a leading position on the national scene, both in production processes and in the inte-gration of supply chains. SP SPA also stands out for its diversification of its offer, which now includes new food products, the result of collaborations with international players.
From 2000, the year of its foundation, until the completion of new production modules in 2021, SP SPA has grown into an integrated plant capable of transforming paddy rice (fielddried rice) into white rice, with an annual production of approximately 120,000 tonnes.
SP SPA is a company looking to the future with an international growth plan, aiming to expand rapidly in Europe and non-EU markets. ‘We have concluded a first phase and now our goal is to grow further, exploiting our production facilities and expertise to bring innovation and quality to a dynamic and evolving market,’ comments Matteo Soppera, Sales Director of SP SPA. ‘We have embarked on a ‘Brand Identity’ path to renew our identity on the market, presenting our products through dedicated lines.’
As part of the new Brand Identity, SP SPA has developed


Nel corso degli anni, SP SPA ha saputo anticipare le tendenze del mercato, diventando un produttore di eccellenza nel settore del riso. Il suo impegno a rispondere alle sfide e cogliere le opportunità ha portato l’azienda a conquistare la fiducia di importanti brand del panorama alimentare internazionale. Con l’introduzione di nuove linee di prodotto, SP SPA ha avviato un percorso verso la sostenibilità, collaborando con partner locali e promuovendo la coltivazione e la cultura del riso. Gli impianti di lavorazione di Stroppiana, tecnologicamente avanzati e completamente automatizzati, conferiscono all’azienda una posizione di leadership nel panorama nazionale, sia nei processi produttivi che nell’integrazione delle filiere. SP SPA si distingue anche per la diversificazione dell’offerta, che oggi include nuovi prodotti alimentari, frutto di collaborazioni con player internazionali. Dal 2000, anno della sua fondazione, fino al completamento di nuovi moduli produttivi nel 2021, SP SPA è cresciuta fino a diventare un impianto integrato in grado di trasformare il risone (riso essiccato in campo) in riso bianco, con una produzione annuale di circa 120.000 tonnellate.
SP SPA è una società che guarda al futuro con un piano di crescita internazionale, puntando ad espandersi rapidamente in Europa e nei mercati extra UE. “Abbiamo concluso una prima fase e ora il nostro obiettivo è crescere ulteriormente, sfruttando il nostro impianto produttivo e la nostra expertise per portare innovazione e qualità a un mercato dinamico e in continua evoluzione”, commenta Matteo Soppera, Direttore Commerciale di SP SPA. “Abbiamo intrapreso un percorso di ‘Brand Identity’ per rinnovare la nostra identità sul mercato, presentando i nostri prodotti attraverso linee dedicate.”
Nell’ambito della nuova Brand Identity, SP SPA ha sviluppato una proposta commerciale e strategica unica, mirata a una maggiore consapevolezza del consumo e ad adattare il riso alle esigenze dei consumatori attraverso diverse linee di prodotto:
• Io Chef Line: risotti pronti di alta qualità.
• Classic Line: qualità nella semplicità.
• Gourmet Line: prodotti speciali per l’alta cucina.
• Bio Line: linea biologica.
• Sensei Line: prodotti per il mercato del sushi.
• Ethnic Line: riso basmati e jasmine.
SP SPA è una delle poche aziende che ha promosso iniziative trasversali, valorizzando il riso in vari settori e promuovendo una cultura più ampia, non limitata alla semplice proposta di riso da cucina.
La visione moderna di SP si consolida nella creazione della linea IO CHEF.
IoChef:
La nuova frontiera del risotto italiano, pronto e gustoso
Nel mondo della gastronomia moderna, la ricerca di soluzioni rapide senza compromettere la qualità è una sfida sempre più presente. IoChef, il marchio che unisce praticità e qualità, si inserisce perfettamente in questa tendenza, proponendo risotti autentici che portano il meglio della cucina italiana direttamente nelle case degli amanti del buon cibo.
La linea IoChef si distingue in due categorie principali, pensate per soddisfare diverse esigenze: Ready to Cook e Ready to Eat. Entrambe le linee offrono un’esperienza culinaria che unisce tradizione, innovazione e velocità, rispondendo così alle necessità di chi vuole gustare un risotto prelibato anche con il tempo limitato a disposizione.
La linea Ready to Cook è perfetta per chi desidera preparare un risotto completo, seguendo i tempi e i rituali della cucina tradizionale. Con 13 varianti di gusto, tra cui classici come il risotto alla zucca e al radicchio, e proposte più innovative come il risotto alle fragole e ai mirtilli, IoChef stimola la creatività culinaria, offrendo piatti che spaziano dalla tradizione alla sperimentazione.
Dall’altro lato, la linea Ready to Eat offre un risotto 100% Made in Italy che si cuoce in 90 secondi al microonde. Perfetto bev food

a unique commercial and strategic proposition aimed at increasing consumer awareness and adapting rice to consumer needs through different product lines:
• Io Chef Line: high quality ready-made risottos.
• Classic Line: quality in simplicity.
• Gourmet Line: special products for haute cuisine.
• Bio Line: organic line.
• Sensei Line: products for the sushi market.
• Ethnic Line: basmati and jasmine rice.
SP SPA is one of the few companies that has promoted transversal initiatives, enhancing the value of rice in various sectors and promoting a broader culture, not limited to the simple pro-posal of cooking rice. SP’s modern vision is consolidated in the creation of the IO CHEF line.
IoChef:
The new frontier of italian risotto, ready and tasty
In the world of modern gastronomy, the search for quick solutions without


compromising on quality is an ever-present challenge. IoChef, the brand that combines convenience and quality, fits perfectly into this trend, offering authentic risottos that bring the best of Italian cuisine di-rectly into the homes of food lovers.
The IoChef line is divided into two main categories, designed to meet different needs: Ready to Cook and Ready to Eat. Both lines offer a culinary experience that combines tradition, innova-tion and speed, meeting the needs of those who want to enjoy a delicious risotto even with li-mited time available.
The Ready to Cook range is perfect for those who want to prepare a perfect risotto, following the times and rituals of traditional cooking. With 13 flavour variations, including classics like pumpkin and radicchio risotto, and more innovative proposals like strawberry and blueberry risotto, IoChef stimulates culinary creativity, offering dishes that range from traditional to ex-perimental.
On the other hand, the Ready to Eat line offers a 100% Made in Italy risotto that cooks in 90 se-conds
in the microwave. Perfect for a quick lunch break or dinner, but without sacrificing quali-ty, this risotto is an ideal solution for those looking for a tasty and nutritious dish without compromise.
The packaging of the two lines reflects the brand philosophy: functionality and elegance. The Ready to Cook line is available in a 300 g format, ideal for four servings, while the Ready to Eat line, with 240 g portions, is designed for a single dish. The sober and elegant graphics commu-nicate the quality of the product, making each package a symbol of sophistication.
IoChef is not just a product, but an invitation to feel like a chef, to experiment and to bring highquality risottos to the table, quick to prepare but rich in flavour. With IoChef, every culina-ry moment becomes a unique experience that never compromises on the goodness and au-thenticity of Italian risotto. spspa.it

per una pausa pranzo o una cena veloce, ma senza rinunciare alla qualità, questo risotto rappresenta una soluzione ideale per chi cerca un piatto saporito e nutriente senza compromessi.
Il packaging delle due linee riflette la filosofia del marchio: funzionalità ed eleganza.
La linea Ready to Cook è disponibile in formato da 300 gr, ideale per quattro porzioni, mentre la linea Ready to Eat, con porzioni da 240 gr, è pensata per un singolo piatto. La
grafica sobria ed elegante comunica la qualità del prodotto, rendendo ogni confezione un simbolo di raffinatezza.
IoChef non è solo un prodotto, ma un invito a sentirsi chef, a sperimentare e a portare in tavola risotti di alta qualità, veloci da preparare ma ricchi di sapore. Con IoChef, ogni momento culinario diventa un’esperienza unica, che non scende mai a compromessi sulla bontà e sull’autenticità del risotto italiano. spspa.it


by Paola Mezzaluna

At TUTTOFOOD 2025, Salumificio Mezzaluna from Fermo brought to the stage the very best of Marche’s charcuterie tradition. Their presence caught the attention of buyers, distributors, and visitors looking for authentic products that tell the story of a territory through unique flavors.
Founded 65 years ago and now run by siblings Paola and Marco Mezzaluna, the company has become a benchmark for those seeking artisanal quality combined with a modern approach, where innovation and sustainability play an increasingly central role.
We spoke with Paola Mezzaluna, co-owner of the company, who told us about the range presented at the fair and the vision that guides the family business today.
Paola, what range of products did you bring to Tuttofood?
Our assortment is quite broad, as we handle inhouse slaughtering and the entire processing. We presented the Ciauscolo IGP, a typical Marche salami and a strong expression of our identity, then the Fermanello, the Double Taste,
A TUTTOFOOD 2025, il Salumificio Mezzaluna di Fermo ha portato in scena il meglio della tradizione salumiera marchigiana. Una presenza che ha attirato l’attenzione di buyer, distributori e visitatori alla ricerca di prodotti autentici, capaci di raccontare un territorio attraverso sapori unici. Fondata 65 anni fa e oggi guidata dai fratelli Paola e Marco Mezzaluna, l’azienda rappresenta un punto di riferimento per chi cerca la qualità artigianale unita a un approccio moderno, in cui innovazione e sostenibilità giocano un ruolo sempre più centrale.
Ne abbiamo parlato con Paola Mezzaluna, co-titolare del salumificio, che ci ha raccontato la gamma presentata in fiera e la visione che accompagna oggi l’attività di famiglia.
Paola, qual è la gamma di prodotti che avete portato a Tuttofood?
I nostri prodotti sono diversi, perché facciamo macellazione interna e tutta la trasformazione. Abbiamo il ciauscolo IGP, che è un salame tipico marchigiano e molto rappresentativo della nostra

a unique filone that combines lean and fat cuts, along with Coppa, Lonzino, Salame con l’ardello, Salame magro, Fiocco di prosciutto, Culatta, and Prosciutto. The fresh hams are salted at the foot of the Sibillini Mountains, an area with a very particular microclimate that gives our products their distinctive character.
Your production is rooted in local tradition but also looks to foreign markets. What has been the response outside Italy?
We have several clients in Europe and also in Northern Italy, where niche products are in high demand.
Those who taste our salumi immediately recognize the difference: they are cured meats that tell our story, crafted with care and respect for artisanal methods. Seeing this appreciation is very rewarding for us.
A family business with a long history. How important are innovation and sustainability for your company today?
They are fundamental. Without innovation, we would have remained stuck in the past, while today it allows us to grow and face new challenges.
Equally important is sustainability: every one of our processes is designed to reduce environmental impact and operate responsibly. It’s a commitment that accompanies every decision we make, because we believe tradition and the future must walk together.
From passion for artisanal craftsmanship to the selection of the finest raw materials, and the adoption of modern technologies, Salumificio Mezzaluna demonstrates how tradition and innovation can come together. Their cured meats remain a shining example of Italian excellence: products that preserve the soul of a territory while speaking to an international market increasingly attentive to authentic quality. www.salumificiomezzaluna.it
identità, poi il fermanello, il doppio gusto, un filone particolare che unisce la parte magra a quella grassa, e ancora la coppa, il lonzino, il salame con l’ardello, il salame magro, il fiocco di prosciutto, la culatta e il prosciutto. Le cosce fresche vengono salate ai piedi dei Monti Sibillini, un’area con un microclima molto particolare che rende possibile ottenere prodotti dal carattere distintivo.
La vostra produzione è radicata nella tradizione locale, ma guarda anche ai mercati esteri. Qual è stata la risposta al di fuori dell’Italia?
Abbiamo diversi clienti in Europa e anche qui al Nord Italia, dove spesso si ricercano prodotti di nicchia.
Chi li assaggia riconosce immediatamente la differenza: sono salumi che raccontano la nostra storia, realizzati con attenzione e rispetto delle regole dell’artigianalità.
Vedere questo apprezzamento è per noi una grande gratificazione.
Un’azienda familiare con una lunga storia. Quanto contano oggi innovazione e sostenibilità per il vostro salumificio?
Sono fondamentali. Senza innovazione ci saremmo fermati, mentre oggi ci consente di crescere e affrontare nuove sfide.
Ma è altrettanto importante la sostenibilità: ogni nostro processo è orientato a ridurre l’impatto sul territorio e a operare con responsabilità.
È un impegno che accompagna ogni nostra scelta, perché crediamo che tradizione e futuro debbano camminare insieme.
Dalla passione per la lavorazione artigianale alla selezione delle materie prime migliori, fino all’adozione di tecnologie moderne, il percorso del Salumificio Mezzaluna dimostra come sia possibile coniugare tradizione e innovazione. I suoi salumi restano un esempio di eccellenza italiana, capaci di custodire l’anima di un territorio e, allo stesso tempo, di parlare a un mercato internazionale sempre più attento alla qualità autentica.
www.salumificiomezzaluna.it






Legionella is a bacterium responsible for a serious lung disease, known as Legionellosis, which can manifest itself in two main forms: Legionnaires’ disease, a severe form of pneumonia, and Pontiac fever, a milder condition that causes pneumonia-like symptoms. flu. Legionellosis is an infectious disease which, if not treated adequately, can be lethal, especially in fragile subjects, such as the elderly, people with compromised immune systems or chronically ill people.
The Legionella bacterium grows in humid and warm environments, such as water pipes, air conditioners and water systems. Its proliferation usually occurs at temperatures between 25°C and 45°C, and transmission occurs through inhalation of contaminated aerosol, i.e. tiny droplets of contaminated water suspended in the air. This makes water and air conditioning systems ideal environments for the growth of Legionella if not properly maintained.
Prevention and risk management Legionellosis
The prevention of Legionellosis is of fundamental importance, not only to avoid the spread of the bacterium and the consequent disease, but also to comply with health regulations and guarantee safe environments. The first step in prevention consists in assessing the risk within buildings, industrial plants and accommodation facilities, such as hospitals, hotels and retirement homes. The Legionellosis risk assessment must be carried out by qualified professionals and must take into consideration several factors, including:
• Temperature control: constantly monitor the water temperature to prevent it from reaching the ideal values for the proliferation of Legionella.
• Cleaning and disinfection: Pipelines, cooling towers and wa-


LEGIONELLA: PREVENZIONE E SERVIZI
DI ANALISI PER LA SICUREZZA AMBIENTALE
La Legionella è un batterio responsabile di una grave malattia polmonare, conosciuta come Legionellosi, che può manifestarsi in due forme principali: la malattia del legionario, una forma grave di polmonite, e la febbre di Pontiac, una condizione più lieve che provoca sintomi simil-influenzali. La Legionellosi è una malattia infettiva che, se non trattata adeguatamente, può risultare letale, specialmente in soggetti fragili, come anziani, persone con il sistema immunitario compromesso o malati cronici.
Il batterio Legionella si sviluppa in ambienti umidi e caldi, come tubature di acqua, condizionatori e impianti idrici. La sua proliferazione avviene solitamente a temperature comprese tra i 25°C e i 45°C, e la trasmissione avviene tramite inalazione di aerosol contaminato, ossia minuscole goccioline di acqua contaminata sospese nell’aria. Questo rende i sistemi di acqua e aria condizionata ambienti ideali per la crescita della Legionella, se non correttamente manutenuti.
Prevenzione e gestione del rischio Legionellosi
La prevenzione della Legionellosi è di fondamentale importanza, non solo per evitare la diffusione del batterio e la conseguente malattia, ma anche per rispettare le normative sanitarie e garantire ambienti sicuri. Il primo passo nella prevenzione consiste nella valutazione del rischio all’interno di edifici, impianti industriali e strutture ricettive, come ospedali, alberghi e case di riposo. La valutazione del rischio Legionellosi deve essere eseguita da professionisti qualificati e deve prendere in considerazione diversi fattori, tra cui:
• Controllo delle temperature: monitorare costantemente la temperatura dell’acqua per evitare che raggiunga i valori ideali per la proliferazione della Legionella.
• Pulizia e disinfezione: le tubazioni, le torri di raffreddamento e gli impianti idrici devono essere periodicamente puliti e disinfettati per eliminare i batteri.
• Perché affidarsi a Saturno laboratorio analisi?
• La Legionella rappresenta un rischio serio per la salute pubblica, ed è necessario adottare misure preventive efficaci per evitare la proliferazione di questo batterio. Grazie alla sua esperienza consolidata e alle tecnologie all’avanguardia, Saturno Laboratorio Analisi offre un servizio altamente competente e preciso, che consente di monitorare la sicurezza degli impianti e prevenire eventuali problemi di Legionellosi.
• Inoltre, la consulenza professionale e il supporto continuo del team di esperti di Saturno Laboratorio Analisi fanno sì che ogni cliente riceva il miglior servizio possibile per garantire un ambiente sano e sicuro, conforme alle normative di settore.
• La salute e la sicurezza delle persone devono essere sempre al primo posto, e per questo è fondamentale rivolgersi a un laboratorio qualificato che possa offrire un’analisi approfondita e precisa dei rischi microbiologici, tra cui quelli legati alla Legionella. Con i servizi di Saturno Laboratorio Analisi, le aziende e le strutture sanitarie possono essere certe di rispettare gli standard più elevati per la prevenzione della Legionellosi e la sicurezza ambientale.
• Ispezioni e analisi regolari: è fondamentale effettuare analisi microbiologiche periodiche per rilevare la presenza di Legionella negli impianti e nelle strutture.
ter systems must be periodically cleaned and disinfected to eliminate bacteria.
• Regular inspections and analyses: it is essential to carry out periodic microbiological analyzes to detect the presence of Legionella in plants and structures.
The services offered by Saturno analysis laboratory
Saturno Laboratorio Analysis stands out for its offer of advanced microbiological analyses, in particular for the assessment of Legionellosis risk. The laboratory offers a range of highly specialized services for the diagnosis, prevention and control of Legionella, including:
1.Microbiological analyzes for Legionella: Saturno Laboratorio Analysis carries out specific tests for the detection of Legionella in water samples, surfaces and environments. The analysis is conducted using advanced techniques such as PCR (polymerase chain reaction), which allows rapid and reliable results on the presence of the bacterium to be obtained.
2.Legionellosis risk assessment: the laboratory offers an in-depth Legionellosis risk assessment, which includes a complete analysis of water and air conditioning facilities, and provides guidance on how to reduce the risk of contamination and improve system management. This service is essential for anyone who manages public buildings, businesses or healthcare facilities.
3.Continuous monitoring: Saturno Laboratorio Analysis also offers continuous monitoring solutions to ensure that Legionella levels remain under control over time. Periodic checks are essential to ensure that the prevention measures adopted are effective and that the environment remains safe for the people who frequent it.
4.Detailed reports and consultations: Once analyzes are completed, the laboratory provides detailed reports, which can be used to meet regulatory obligations and implement corrective measures if necessary. Furthermore, Saturno Laboratorio Analysis offers specialist consultancy to guide companies in managing risks related to Legionella.
5.Personalized services: each customer has specific needs, and Saturno Laboratorio Analysis is able to offer customized solutions for
different types of systems, both for large industrial structures and for small and medium-sized enterprises. The laboratory is able to adapt to any need, guaranteeing high quality services
Why rely on Saturno analysis laboratory?
Legionella represents a serious risk to public health, and it is necessary to adopt effective preventive measures to avoid the proliferation of this bacterium. Thanks to its consolidated experience and cutting-edge technologies, Saturno Laboratorio Analysis offers a highly competent and precise service, which allows you to monitor the safety of the systems and prevent any Legionellosis problems.
Furthermore, the professional consultancy and continuous support of the Saturno Laboratorio Analysis team of experts ensure that each customer receives the best possible service to guarantee a healthy and safe environment, compliant with sector regulations.
The health and safety of people must always come first, and for this reason it is essential to turn to a qualified laboratory that can offer an in-depth and precise analysis of microbiological risks, including those linked to Legionella. With the services of Saturno Laboratorio Analysis, companies and healthcare facilities can be sure of complying with the highest standards for the prevention of Legionellosis and environmental safety.
www.saturnolab.it

I servizi offerti da Saturno laboratorio analisi Saturno Laboratorio Analisi si distingue per la sua offerta di analisi microbiologiche avanzate, in particolare per la valutazione del rischio Legionellosi. Il laboratorio offre una gamma di servizi altamente specializzati per la diagnosi, prevenzione e controllo della Legionella, tra cui:
1. Analisi microbiologiche per la Legionella: Saturno Laboratorio Analisi esegue test specifici per la rilevazione della Legionella in campioni di acqua, superfici e ambienti. L’analisi viene condotta tramite tecniche avanzate come la PCR (reazione a catena della polimerasi), che consente di ottenere risultati rapidi e affidabili sulla presenza del batterio.
2. Valutazione del rischio Legionellosi: il laboratorio offre una valutazione approfondita del rischio Legionellosi, che include un’analisi completa delle strutture idriche e di climatizzazione, e fornisce indicazioni su come ridurre il rischio di contaminazione e migliorare la gestione dei sistemi. Questo servizio è essenziale per chiunque gestisca edifici pubblici, aziende o strutture sanitarie.
3. Monitoraggio continuo: Saturno Laboratorio Analisi propone anche soluzioni di monitoraggio continuo per garantire che i livelli di Legionella rimangano sotto controllo nel tempo. I controlli periodici sono essenziali per assicurarsi che le misure di prevenzione adottate siano efficaci e che l’ambiente rimanga sicuro per le persone che lo frequentano.
4. Rapporti dettagliati e consulenze: una volta completate le analisi, il laboratorio fornisce rapporti dettagliati, che possono essere utilizzati per soddisfare gli obblighi normativi e per attuare misure correttive, se necessario. Inoltre, Saturno Laboratorio Analisi offre con-
sulenze specialistiche per orientare le aziende nella gestione dei rischi legati alla Legionella.
5. Servizi personalizzati: ogni cliente ha esigenze specifiche, e Saturno Laboratorio Analisi è in grado di offrire soluzioni personalizzate per le diverse tipologie di impianti, sia per le grandi strutture industriali che per le piccole e medie imprese. Il laboratorio è in grado di adattarsi a qualsiasi esigenza, garantendo servizi di alta qualità.
Perché affidarsi a Saturno laboratorio analisi?
La Legionella rappresenta un rischio serio per la salute pubblica, ed è necessario adottare misure preventive efficaci per evitare la proliferazione di questo batterio. Grazie alla sua esperienza consolidata e alle tecnologie all’avanguardia, Saturno Laboratorio Analisi offre un servizio altamente competente e preciso, che consente di monitorare la sicurezza degli impianti e prevenire eventuali problemi di Legionellosi.
Inoltre, la consulenza professionale e il supporto continuo del team di esperti di Saturno Laboratorio Analisi fanno sì che ogni cliente riceva il miglior servizio possibile per garantire un ambiente sano e sicuro, conforme alle normative di settore. La salute e la sicurezza delle persone devono essere sempre al primo posto, e per questo è fondamentale rivolgersi a un laboratorio qualificato che possa offrire un’analisi approfondita e precisa dei rischi microbiologici, tra cui quelli legati alla Legionella. Con i servizi di Saturno Laboratorio Analisi, le aziende e le strutture sanitarie possono essere certe di rispettare gli standard più elevati per la prevenzione della Legionellosi e la sicurezza ambientale.
www.saturnolab.it
The Trani-based company launches Altograno and Karshof taralli, combining research, health and sustainability
Altograno® flour and Karshof flour: two innovations that transform the Apulian taralli into a nutritious and sustainable product
Trani - Tradition and innovation meet in the new challenge of Tentazioni Pugliesi, an Apulian company specialising in the production of artisan taralli. Thanks to the careful work of its research and development department, the company has launched two new products that promise to revolutionise the sector: the Altograno taralli, made with Altograno® flour, and the Karshof taralli, obtained from Karshof flour, a vegetable flour derived from agro-industrial artichoke waste.
These new variants respond to the growing demand for healthy and sustainable food, without renouncing the authentic taste of Apulian tradition. With a focus on the quality of raw materials and the use of innovative processes, Tentazioni Pugliesi confirms itself as a benchmark in the food sector, skilfully combining craftsmanship and research.

TENTAZIONI PUGLIESI RIVOLUZIONA I TARALLI: INNOVAZIONE E BENESSERE NEL CUORE DELLA
TRADIZIONE
L’azienda di Trani lancia i taralli Altograno e Karshof, unendo ricerca, salute e sostenibilità
Farina Altograno® e farina Karshof: due innovazioni che trasformano il tarallo pugliese in un prodotto nutriente e sostenibile
Trani – Tradizione e innovazione si incontrano nella nuova sfida di Tentazioni Pugliesi, azienda pugliese specializzata nella produzione di taralli artigianali. Grazie a un attento lavoro del reparto ricerca e sviluppo, l’azienda ha lanciato due nuovi prodotti che promettono di rivoluzionare il settore: i taralli Altograno, realizzati con la farina Altograno®, e i taralli Karshof, ottenuti dalla farina Karshof, una farina vegetale derivata dagli scarti agro-industriali del carciofo.
Queste nuove varianti rispondono alla crescente domanda di alimenti sani e sostenibili, senza rinunciare al gusto autentico della tradizione pugliese. Con un focus sulla qualità delle materie prime e l’utilizzo di processi innovativi, Tentazioni Pugliesi si conferma un punto di riferimento nel settore alimentare, coniugando sapientemente artigianalità e ricerca.
Taralli Altograno: la rivoluzione del grano duro
I taralli Altograno nascono da una fusione perfetta tra tradizione e tecnologia grazie all’utilizzo della farina Altograno®, una farina nutriente e genuina ottenuta esclusivamente da grano duro. La sua particolarità risiede nel metodo di lavorazione esclusivo denominato Lavorazione Circolare®, che preserva al massimo le proteine e le fibre più preziose del chicco, garantendo un prodotto sano, equilibrato e ricco di nutrienti.
Cos’è la Lavorazione Circolare®?
Si tratta di un processo innovativo che, durante la macinazione, seleziona e conserva le parti più nobili del chicco:
• Germe di grano e aleurone, ricchi di proteine e fibre, vengono separati con cura dall’olio del germe.
• I nutrienti essenziali vengono reinseriti nella semola, mantenendo inalterato il gusto autentico del grano duro.
Questo metodo permette di ottenere una farina dal profilo nutrizionale superiore, ideale per chi cerca un prodotto salutare e naturale senza compromessi sul sapore. I taralli Altograno, dunque, si distinguono per la loro leggerezza e croccantezza, rappresentando un’alternativa perfetta ai taralli tradizionali per chi desidera uno spuntino sano e gustoso.



Taralli Altograno: the durum wheat revolution
The Altograno taralli are born from a perfect fusion of tradition and technology thanks to the use of Altograno flour® , a nutritious and genuine flour obtained exclusively from durum wheat. Its uniqueness lies in the exclusive processing method called Circular Processing®, which preserves the grain’s most valuable proteins and fibres to the maximum, guaranteeing a healthy, balanced and nutrient-rich product.
It is an innovative process that, during milling, selects and preserves the noblest parts of the grain:
• Wheat germ and aleurone, rich in protein and fibre, are carefully separated from the germ oil.
• The essential nutrients are reinserted into the semolina, preserving the authentic taste of durum wheat.
This method results in a flour with a superior nutritional profile, ideal for those seeking a healthy, natural product without compromising on flavour. The Altograno taralli, therefore, stand out for their lightness and crunchiness, representing a perfect alternative to traditional taralli for those who want a healthy and tasty snack.
Karshof taralli: sustainable innovation with artichoke flour
The other great innovation from Tentazioni Pugliesi is the Karshof taralli, a product that combines wellness and sustainability. Made with Karshof flour, a vegetable flour derived from the agro- industrial waste of artichokes, these taralli represent a true revolution in the sector.
This flour, completely gluten-free, is a concentrate of beneficial properties:
• 60% fibre, useful for intestinal health and digestion.
• 13% protein, for a balanced nutritional intake.
• 6% inulin, a natural prebiotic that promotes intestinal well-being.
In addition to its high nutritional value, Karshof flour is also a rich source of antioxidants, including cynarin, a compound known for its cleansing and protective properties for the liver and intestines. Its low glycemic index makes it an excellent choice for diabetics, while its iron, potassium and vitamin K content makes it an ally for healthy bones, heart and nervous system.
This innovation is a clear example of circular economy, in which waste from the agro-food industry is valorised to create new healthy and sustainable products.
With the Altograno and Karshof taralli, Tentazioni Pugliesi demonstrates that it is possible to innovate while respecting tradition and responding to the needs of an increasingly health- and environment-conscious market.
The search for quality ingredients and the adoption of state-of-the- art production processes allow the Trani-based company to stand out in the sector, offering genuine products that combine taste, nutrition and sustainability.
The company has also embarked on a path to optimise resources and reduce waste, adopting ecofriendly packaging solutions and promoting the use of local raw materials.
With this new product range, Tentazioni Pugliesi confirms its desire to bring the Apulian tarallo into a new era, keeping tradition alive but enriching it with new technologies and innovative raw materials.
The Altograno and Karshof taralli represent an evolution of the classic tarallo, adapting it to the needs of those who want a balanced and conscious diet.
The objective is clear: to propose healthy, tasty and sustainable snacks, capable of conquering the Italian and international market.
Tentazioni Pugliesi thus continues to distinguish itself as a pioneering company that focuses on quality and innovation without forgetting its roots.
www.tentazionipugliesi.it

Taralli Karshof: innovazione sostenibile con la farina di carciofo
L’altra grande novità firmata Tentazioni Pugliesi è rappresentata dai taralli Karshof, un prodotto che unisce benessere e sostenibilità. Realizzati con la farina Karshof, una farina vegetale derivata dagli scarti agro-industriali del carciofo, questi taralli rappresentano una vera rivoluzione nel settore.
Questa farina, completamente priva di glutine, è un concentrato di proprietà benefiche:
• 60% di fibre, utili per la salute intestinale e la digestione.
• 13% di proteine, per un apporto nutrizionale equilibrato.
• 6% di inulina, un prebiotico naturale che favorisce il benessere intestinale.
Oltre al suo alto valore nutrizionale, la farina Karshof è anche una ricca fonte di antiossidanti, tra cui la cinarina, un composto noto per le sue proprietà depurative e protettive per fegato e intestino. Il basso indice glicemico la rende un’ottima scelta per i diabetici, mentre il contenuto di ferro, potassio e vitamina K la rende un alleato per la salute delle ossa, del cuore e del sistema nervoso. Questa innovazione è un chiaro esempio di economia circolare, in cui gli scarti dell’industria agroalimentare vengono valorizzati per creare nuovi prodotti sani e sostenibili.
Benessere e sostenibilità: la mission di Tentazioni Pugliesi Con i taralli Altograno e Karshof, Tentazioni Pugliesi dimostra che è possibile innovare rispettando la tradizione e rispondendo alle esigenze di un mercato sempre più attento alla salute e all’ambiente. La ricerca di ingredienti di qualità e l’adozione di processi produttivi all’avanguardia permettono all’azienda di Trani di distinguersi nel settore, offrendo prodotti genuini che combinano gusto, nutrizione e sostenibilità.
L’azienda ha inoltre avviato un percorso di ottimizzazione delle risorse e riduzione degli sprechi, adottando soluzioni eco-compatibili per il packaging e promuovendo l’utilizzo di materie prime locali.
Un futuro all’insegna dell’innovazione
Con questa nuova gamma di prodotti, Tentazioni Pugliesi conferma la sua volontà di portare il tarallo pugliese in una nuova era, mantenendo viva la tradizione ma arricchendola con nuove tecnologie e materie prime innovative. I taralli Altograno e Karshof rappresentano un’evoluzione del tarallo classico, adattandolo alle esigenze di chi vuole un’alimentazione equilibrata e consapevole.
L’obiettivo è chiaro: proporre snack sani, gustosi e sostenibili, capaci di conquistare il mercato italiano e internazionale. Tentazioni Pugliesi continua così a distinguersi come un’azienda all’avanguardia, che punta sulla qualità e sull’innovazione senza dimenticare le proprie radici.
www.tentazionipugliesi.it
Pasticiotto was born in Galatina almost three centuries ago. A simple pastry that became an identity symbol and an international ambassador for Salento. From the hands that still knead it today, passing on traditions that withstand time, begins the journey of (N)ever Enough, the fourth edition of Yeast Photo Festival (Italy, Matino and Salento, September 25 – November 9), where food turns into image, narrative and memory.
In Matino, the absolute protagonist is Martin Parr with Snack It!, more than sixty photographs that transform food into a mirror of our daily obsessions. With his sharp, ironic gaze, Parr dismantles consumer society through dripping ice creams, crooked sandwiches and couples bored at the table. It is not just photography: it is a visual atlas of our rituals, exposing the grotesque side of everyday life.


DAL PASTICCIOTTO A PARR: IL CIBO COME RACCONTO A YEAST PHOTO FESTIVAL
Il pasticciotto è nato a Galatina, quasi tre secoli fa. Un dolce semplice, capace di diventare simbolo identitario e ambasciatore internazionale del Salento. È dalle mani che lo impastano, tramandando tradizioni che resistono al tempo, che parte anche il viaggio di (N)ever Enough, quarta edizione di Yeast Photo Festival (Matino e Salento, 25 settembre – 9 novembre), dove il cibo diventa immagine, racconto e memoria.
A Matino, protagonista assoluto è Martin Parr con Snack It!, oltre sessanta fotografie che trasformano il cibo in uno specchio delle nostre ossessioni quotidiane. Con il suo sguardo ironico e tagliente, Parr smonta la società dei consumi attraverso gelati che colano, panini storti e coppie annoiate davanti a un piatto. Non è solo fotografia: è un atlante visivo dei nostri rituali, capace di svelare il lato grottesco del quotidiano.


If Parr captures the instant, Blake Little with Preservation freezes it in honey. Bodies immersed in an archaic fluid become sweet, dripping sculptures, allegories of fragility and memory. With Taste & Track, French curator Artur Mettetal takes us on board the Orient Express: standardized carriages, rigid plastic tableware, printed menus. Minimal objects that tell thirty years of food culture in motion, restoring to travel its symbolic value.
It is in Galatina that the duo FLAVIO&FRANK present Buone Mani, a project dedicated to the gestures that preserve the gastronomic identity of a territory: from Pasticiotto, born here and now a global icon, to traditional products that still endure thanks to artisanal skill.
Thus Yeast builds a mosaic where food is not just nourishment but language: from the domestic table to the railway carriage, from the artisan’s workshop to Parr’s irreverent images. A journey that reminds us how every bite carries stories, identities and transformations. www.yeastphotofestival.it





Se Parr fotografa l’istante, Blake Little con Preservation lo congela nel miele. Corpi immersi in un fluido arcaico diventano sculture dolci e sgocciolanti, allegorie della fragilità e della memoria. Con Taste & Track, il francese Artur Mettetal ci porta sui binari dell’Orient Express: carrozze standardizzate, stoviglie di plastica rigida, menù stampati. Oggetti minimi che raccontano trent’anni di cultura alimentare in movimento, restituendo al viaggio il suo valore simbolico.
E proprio a Galatina il duo FLAVIO&FRANK presenta Buone Mani, progetto dedicato ai gesti che custodiscono l’identità gastronomica di un territorio: dal pasticciotto, nato qui e divenuto icona globale, ai prodotti tradizionali che ancora resistono grazie alla manualità artigiana.
Così Yeast costruisce un mosaico in cui il cibo non è solo nutrimento ma linguaggio: dalla tavola domestica al vagone ferroviario, dal laboratorio artigiano alle immagini dissacranti di Parr. Un percorso che ci ricorda come ogni boccone porti con sé storie, identità e trasformazioni.
www.yeastphotofestival.it

The “Orsobianco formula” that has proved winning on shelves since 1993
In 1993, the packaged croissant market was dominated by industrial products. Orsobianco made a bold, countertrend move by introducing the first high-quality croissant with a natural shelf life. Thirty years later, this bet continues to reward buyers who prioritize market trends and point-of-sale profitability.
Today, Orsobianco is a “creator of excellence,” offering lines such as Essenza and Armonia, designed from the packaging onward to maximize shelf profitability. Thanks to their premium perception among consumers, Orsobianco croissants deliver up to +400% higher returns per linear meter compared to competitors. How is this possible? Through a meticulous 72-hour production process, the use of stonemilled flours, jams containing at least 60% fruit, and the complete absence of preservatives, alcohol, or GMO ingredients.
The 90-day shelf life, shorter than the 6-7 months of industrial croissants, is a guarantee of freshness and natural quality that appeals to a growing audience of quality-conscious consumers. Additionally, just-in-time production ensures fresh deliveries to




ZERO MONO E DIGLICERIDI, +400% REDDITIVITÀ
La “formula Orsobianco” che vince sugli scaffali dal 1993
Nel 1993 il mercato dei croissant confezionati era dominato da prodotti industriali. Orsobianco ha fatto una scommessa in controtendenza e ha introdotto il primo croissant di alta qualità con shelf life naturale. Una scommessa che, trent’anni dopo, continua a premiare i buyer più attenti alle tendenze di mercato e alla redditività del punto vendita.
Oggi, Orsobianco è un “creatore di eccellenze” con linee come Essenza e Armonia, progettate fin dal packaging per massimizzare la redditività dello spazio a scaffale.
Grazie alla percezione premium da parte dei consumatori, i croissant Orsobianco generano fino al +400% di resa per metro lineare rispetto ai concor-
bev food
retail locations without requiring them to hold excess stock, providing buyers with 100% supply reliability.
Real consumer testimonials highlight the product’s appeal: “Orsobianco croissants are the best packaged ones. And you can taste the difference from the first bite!” These emotional connections foster loyalty not only to the brand but also to the stores that carry it.
Distributing Orsobianco means achieving an average annual growth of 10% for this product line, which is perceived as a premium one by families searching store shelves for a more wholesome and digestible croissant. This high-end positioning not only drives sales but also enhances the overall quality perception of the entire retail location.
To discover how the ‘Orsobianco formula’ can boost your store’s profitability, contact us at +39 0171 902 304, or write to info@orsobiancodolciaria.com
orsobiancodolciaria.com




renti. Com’è possibile? Grazie a una lavorazione che richiede 72 ore, la scelta di farine macinate a pietra, confetture con almeno il 60% di frutta, e l’assenza totale di conservanti, alcol o ingredienti OGM.
La shelf life di 90 giorni, inferiore rispetto ai 6-7 mesi del croissant industriale, rappresenta una garanzia di freschezza e naturalezza che attrae un pubblico sempre più attento alla qualità.
Inoltre, la produzione just in time permette di consegnare al punto vendita prodotti freschi senza che debba accumulare stock di magazzino, offrendo ai buyer una sicurezza di fornitura al 100%.
Testimonianze reali dei consumatori confermano il gradimento del prodotto: “I croissant Orsobianco sono i migliori confezionati. La differenza si
sente al primo morso!”, raccontano le recensioni. Questo legame emozionale si traduce in fidelizzazione non solo per il marchio, ma anche per il punto vendita che lo ospita.
Distribuire Orsobianco significa crescere in media del 10% l’anno per questa linea prodotti percepita come Premium dalle famiglie in cerca tra gli scaffali di un croissant più genuino e digeribile.
Un posizionamento alto di gamma che contribuisce a elevare la percezione qualitativa dell’intero punto vendita.
Per scoprire come la ‘formula Orsobianco’ incrementa la redditività del vostro punto vendita contattateci al +39 0171 902 304 o scriveteci a info@orsobiancodolciaria.com orsobiancodolciaria.com
Nestled in the Umbrian countryside, Le Cerque is a small, family-run agriturismo that embraces sustainability as a way of life. With a deep respect for the land, its approach combines traditional agricultural methods with modern solutions to reduce environmental impact, while offering guests an authentic countryside experience.
Sustainability is at the core of Le Cerque’s daily operations. The agriturismo produces 6,000 bottles of wine and 1,200 liters of olive oil annually, all cultivated organically. Looking toward the future, it has set a goal to become fully sustainable by 2030.
Ongoing efforts include the installation of solar panels, which have now made the property 80% energy self-sufficient. The agriturismo has also focused on reducing waste by implementing composting practices and sourcing ingredients locally for its farmto-table meals. These initiatives help preserve local traditions in an environmentally conscious way.
Small and medium-sized businesses like Le Cerque are key players in reshaping Italy’s tourism industry. Unlike large hotel chains, which represent only a small fraction of the country’s accommodations,



agriturismos and family-run enterprises form the backbone of Italy’s hospitality sector. Their close ties to local environments and communities place them in a unique position to lead the transition toward more sustainable tourism models.
Le Cerque is deeply connected to the local community, working closely with neighboring businesses to create a network of mutual support. From guided hikes led by local experts to hands-on ceramics workshops with artisans who have perfected their craft over generations, these collaborations are about more than just enhancing the guest experience—they sustain local livelihoods.
For Le Cerque, sustainability is as much about practicality as it is about responsibility. The agriturismo integrates eco-friendly initiatives into its daily oper-



ations, like minimizing waste and repurposing organic materials for compost. Guests are invited to experience these efforts firsthand, through seasonal harvests and tasting sessions that highlight the connection between local agriculture and sustainable traveling.
By integrating environmentally responsible practices with traditional hospitality, Le Cerque is part of a broader movement of small agriturismos across Italy embracing sustainability. As these businesses evolve together, they are not only preserving their heritage, but also creating a network of resilience and shared progress. Their collective efforts are shaping a tourism industry that respects the land, supports local economies, and continues to thrive in the future.
www.lecerque.com
“
Natural fermentation is no longer just a traditional method of preservation - it’s now at the heart of modern gastronomy. From sourdough to kombucha, this ancient practice is driving innovation in kitchens, capturing the attention of chefs, consumers, and producers alike.
There is a subtle thread that connects the peasant cuisine of the past with the most innovative trends in contemporary gastronomy, and that is natural fermentation. Once an ingenious way to preserve food longer, today fermentation has returned as a protagonist in a narrative that blends health, flavor, and territorial identity. Naturally leavened bread, kefir, kombucha, lacto-fermented vegetables, and even miso and soy sauce reinterpreted with Italian raw materials are now

by our editorial team

increasingly common on restaurant menus and on supermarket shelves. It is not a nostalgic revival but a conscious rediscovery that fascinates both health-conscious consumers and chefs in search of complex, authentic flavors.
The world of spontaneous fermentations thrives on the ability of microorganisms to transform raw materials into products that are more digestible, rich in aromas, and packed with functional properties. It is a process that partly escapes industrial control and for this reason conveys a sense of naturalness and uniqueness that is difficult to replicate. It is no surprise that small farms, food start-ups, and even major brands have begun investing in this sector, creating dedicated product lines or collaborations with artisan laboratories. From a commercial perspective, fermentation has become a real driver of innovation: not only because it enriches the market with distinctive products, but because it meets the growing demand for “living” foods, capable of telling a story and standing out.
Farm stays, restaurants, and hotels that choose to include fermented products in their offerings give customers not only a new taste experience but also a cultural message, built on authenticity and care for well-being. It is a trend with enormous potential for growth that, while recalling ancient practices, speaks the most current language of contemporary gastronomy.



Amid the shimmering waters of the Vercelli countryside and the rolling hills of Monferrato lies the Convento Resort, a place where the past and present blend in perfect harmony. Built in 1475 by the will of Guglielmo VIII Paleologo, this historic building, surrounded by rice fields and close to the sacred Bosco delle Sorti, is a testament to elegance and history through the centuries.
Its 19th-century façade, framed by blooming gardens and shaded paths, welcomes guests with grace and charm. Today, after a meticulous restoration completed in 2011, the Convento has become a resort hotel that combines ancient charm with modern comfort, preserving its tradition of hospitality.
The hotel features 13 bright and comfortable rooms, thoughtfully decorated and inspired by the natural colors of the surrounding landscape. The suites offer privacy and convenience, while common areas such as gardens and cozy lounges invite relaxation. Every detail, from curtains to bed linens, reflects the beauty of the outdoor scenery, creating a unique atmosphere.
Enhancing the Convento’s appeal is the Church of Maria Ausiliatrice, a consecrated chapel dating back to the early 20th century, where religious and civil ceremonies can be celebrated. This venue is also ideal for weddings and bespoke events, with elegant 18th-century pavilions adding to its charm.

Tra i riflessi d’acqua che disegnano la campagna vercellese e le colline del Monferrato, sorge il Convento di Trino, un luogo dove passato e presente si intrecciano in un’armonia perfetta. Costruito nel 1475 per volere di Guglielmo VIII Paleologo, questo edificio storico, circondato da risaie e vicinissimo al Bosco delle Sorti, un tempo sacro, è un esempio di eleganza e storia che attraversa i secoli.
La sua facciata ottocentesca, incorniciata da giardini fioriti e viali ombrosi, accoglie gli ospiti con grazia e riservatezza. Oggi, grazie a un accurato restauro completato nel 2011, il Convento è un resort hotel che combina il fascino antico con il comfort moderno, mantenendo viva la tradizione di ospitalità.
L’hotel offre 13 camere luminose e confortevoli, arredate con cura e arricchite dai colori della natura circostante. Le suite garantiscono privacy e comodità, mentre gli spazi comuni, come giardini e salette relax, invitano al riposo. Ogni dettaglio, dai tendaggi alle lenzuola, si ispira alla bellezza del paesaggio esterno, creando un’atmosfera unica.
A impreziosire il Convento, la Chiesetta di Maria Ausiliatrice, consacrata e risalente agli inizi del ‘900, dove si celebrano riti religiosi e civili. Questa location è ideale anche per matrimoni ed eventi personalizzati, grazie ai suoi raffinati padiglioni settecenteschi.


A highlight of the Convento is the Massimo Restaurant, relocated in 2011 from its historic citycenter location. Led by Chef Giorgio Bonato, it offers a cuisine that celebrates local ingredients, such as truffles, mushrooms, and frogs, while incorporating international influences.
Recognized by prestigious gastronomic guides, the restaurant stands out for its quality and creativity, complemented by an extensive selection of wines and spirits.
The Convento of Trino is more than a resort: it is a journey through the beauty, flavors, and history of a treasured corner of Piedmont.
www.ilconventoditrino.com





Fiore all’occhiello è il ristorante Massimo, trasferitosi nel 2011 dalla storica sede cittadina. Guidato dallo chef Giorgio Bonato, propone una cucina che esalta i prodotti del territorio – come tartufi, funghi e rane – e integra influenze internazionali. Segnalato dalle migliori guide gastronomiche, il ristorante si distingue per qualità e creatività, accompagnate da una vasta selezione di vini e distillati.
Il Convento di Trino è più di un resort: è un viaggio nella bellezza, nel gusto e nella storia di un angolo prezioso del Piemonte.
www.ilconventoditrino.com

In the heart of Italian gastronomic culture, where traditional craftsmanship is intertwined with attention to sustainability and technical precision, stands Molini Ambrosio, a company that has been a benchmark for high-quality flour for more than a century. Founded with a clear mission: to transform wheat into an ingredient capable of enhancing the creativity of pizza makers, bakers and pastry chefs, Molini Ambrosio remains the ideal partner for those seeking excellence.
Molini Ambrosio’s history is rooted in solid family knowledge, where every grain of wheat is processed with care and respect. Rigorous selection of raw materials and optimized milling methods guarantee an impeccable end product. Values such as precision, reliability and dialogue with industry professionals are at the heart of the company’s philosophy. Molini Ambrosio, however, does not just preserve its long experience: the company embraces modernity with constant technological research and a strong commitment to sustainability.


MOLINI AMBROSIO: ECCELLENZA, SOSTENIBILITÀ E RICERCA DEL GUSTO NELL’ARTE BIANCA
Nel cuore della cultura gastronomica italiana, dove la tradizione artigianale si intreccia con l’attenzione alla sostenibilità e alla precisione tecnica, sorge Molini Ambrosio, un’azienda che da oltre un secolo rappresenta un punto di riferimento per le farine di alta qualità. Fondata con una missione chiara: trasformare il grano in un ingrediente capace di esaltare la creatività di pizzaioli, panettieri e pasticceri, Molini Ambrosio continua a essere il partner ideale per chi cerca l’eccellenza.
La storia di Molini Ambrosio affonda le sue radici in un solido sapere familiare, dove ogni chicco di grano viene lavorato con cura e rispetto. La selezione rigorosa delle materie prime e i metodi di macinazione ottimizzati garantiscono un prodotto finale impeccabile. Valori come precisione, affidabilità e dialogo con i professionisti del settore sono al centro della filosofia aziendale. Molini Ambrosio, tuttavia, non si limita a custodire la sua lunga esperienza: l’azienda abbraccia la modernità con una costante ricerca tecnologica e un forte impegno per la sostenibilità.

A partner for taste professionals Molini Ambrosio goes beyond the production of flour. Each blend is the result of an ongoing discussion with industry professionals to meet specific needs with targeted solutions.
Whether it’s a pizzaiolo looking for a soft and digestible dough, a baker who wants a crisp and fragrant crust, or a pastry chef looking for maximum technical performance, Molini Ambrosio flours are designed to ensure superior performance.
Collaboration with experts such as Filippo Rosato, master baker and pizza maker, and Giuseppe Maglione, pizza maker of excellence, is a unique added value. These partnerships allow for authentic and innovative synergies, developing products that enhance craftsmanship and tell a story of passion and expertise.
Technological precision and sustainability
Innovation for Molini Ambrosio translates into a perfect combination of technological research and attention to sustainability. Thanks to the use of state-of-the-art milling systems, the company is able to offer flours of consistent quality, tailored to the specific needs of professionals. In addition, a commitment to the responsible use of resources is reflected in production processes with a low environmental impact, fostering a more ethical and conscious future for the food industry. This dedication to technical precision and sustainability distinguishes Molini Ambrosio as a true benchmark. It is not just about flour: it is the ability to create a product that enhances the identity of its users, combining quality, performance and responsibility.
www.moliniambrosio.com

Un partner per i professionisti del gusto Molini Ambrosio va oltre la produzione di farina. Ogni miscela è il frutto di un confronto continuo con i professionisti del settore, per rispondere a esigenze specifiche con soluzioni mirate.
Che si tratti di un pizzaiolo alla ricerca di un impasto soffice e digeribile, di un panettiere che desidera una crosta croccante e fragrante, o di un pasticciere in cerca della massima resa tecnica, le farine Molini Ambrosio sono progettate per garantire performance superiori.
La collaborazione con esperti come Filippo Rosato, maestro della panificazione e della pizza, e Giuseppe Maglione, pizzaiolo d’eccellenza, rappresenta un valore aggiunto unico. Queste partnership permettono di creare sinergie autentiche e innovative, sviluppando prodotti che valorizzano l’artigianalità e raccontano una storia di passione e competenza.
Precisione tecnologica e sostenibilità
L’innovazione per Molini Ambrosio si traduce in una perfetta combinazione di ricerca tecnologica e attenzione alla sostenibilità. Grazie all’utilizzo di sistemi di macinazione all’avanguardia, l’azienda è in grado di offrire farine dalla qualità costante, personalizzate in base alle esigenze specifiche dei professionisti. Inoltre, l’impegno per un utilizzo responsabile delle risorse si concretizza in processi produttivi a basso impatto ambientale, promuovendo un futuro più etico e consapevole per il settore alimentare.
Questa dedizione alla precisione tecnica e alla sostenibilità distingue Molini Ambrosio come un vero e proprio punto di riferimento. Non è solo questione di farina: è la capacità di creare un prodotto che esalta l’identità di chi lo utilizza, unendo qualità, prestazioni e responsabilità
www.moliniambrosio.com
In June 2026, the eyes of the global savoury snacks industry will turn to Lisbon, Portugal, where SNACKEX — the sector’s flagship exhibition — comes to the FIL Expo Centre. Taking place on 17 – 18 June, this two-day event promises to be more than just a trade show. It is the definitive gathering for anyone involved in the manufacture, supply, or innovation of savoury snacks and snack nuts.
SNACKEX is unique in its exclusive focus on this fast-growing sector. As the only international trade fair solely dedicated to savoury snacks, it has established itself as an essential meeting point for buyers and suppliers looking to shape the future of the industry.
For exhibitors, SNACKEX is more than an opportunity — it’s a strategic platform. With over 70% of previous attendees influencing purchasing decisions, it offers direct access to the people who matter.
Whether you’re launching a new product, seeking international exposure, or strengthening relationships with current customers, the show floor is where deals are made and innovation is showcased.
Attendees can expect a rich mix of qualified visitors, from senior executives and procurement specialists to engineers and product developers. In 2026, SNACKEX will again welcome buyers from over 70 countries, offering unparalleled networking opportunities and the potential to open doors to new global markets.



A showcase of innovation and capability
Exhibitors span the entire value chain — from snack producers to equipment manufacturers and ingredient suppliers. Expect to see leading companies presenting innovations in potato and corn chips, popcorn, baked and extruded snacks, as well as the latest in meat snacks and nut-based products. The event also features cutting-edge technology in weighing, packaging, extrusion, processing, and quality control. 2026 show will also spotlight services like consulting, paperless production metrics, and compliance solutions that are driving operational excellence across factories worldwide.
Visitors to SNACKEX represent a broad and influential cross-section of the snack food industry. From senior directors at top global snack brands to R&D leaders scouting for the next big idea, and from engineers sourcing equipment to brokers and

buyers forging new supplier relationships — this is where industry-defining conversations happen. Retail representatives and companies with specific challenges will also be in attendance, looking for tailored solutions and one-on-one engagements with trusted partners and new suppliers alike.
The bottom line SNACKEX isn’t just another event — it’s where deals get done, partnerships are formed, and the future of the savoury snacks sector is shaped. Whether you’re a long-time industry leader or an emerging player with a game-changing idea, Lisbon in June 2026 is where you need to be. Don’t miss your chance to be part of the industry’s most targeted and high-value exhibition.
For all enquiries please email . veronica@esasnacks.eu and keep an eye on snackex.com for early registration to visit





















by Giovanni Lettieri sales manager of Lucana Salumi


Since 1969, Lucana Salumi has carried on the charcuterie tradition of Basilicata, combining farming roots, high-quality raw materials, and a constant focus on innovation.
At TUTTOFOOD 2025, the company showcased its specialties, reaffirming its strong bond with the territory and its ambition to expand across both national and international markets.
Giovanni, which specialty did you highlight at Tuttofood?
We presented our flagship product, the Lucanica di Picerno, which has obtained Protected Geographical Indication (PGI) status and will be launched on the market this summer under the IGP label.
What makes this product unique?
It represents the strong connection our company has with the territory. It starts with our name, Lucana Salumi, and continues with the tradition, care, and craftsmanship we dedicate to each product.
It is born out of respect for the knowledge of our farmers and today reaches Italian tables, blending tradition with the technological innovation the market now requires.
Dal 1969 Lucana Salumi porta avanti la tradizione salumiera della Basilicata, con una produzione che unisce radici contadine, qualità delle materie prime e sguardo rivolto all’innovazione. A TUTTOFOOD 2025 l’azienda ha presentato le sue specialità, confermando il legame con il territorio e la volontà di crescere anche sui mercati nazionali e internazionali.
Giovanni, quale specialità avete portato in primo piano a Tuttofood?
Abbiamo presentato il nostro prodotto di punta, la Lucanica di Picerno, che ha ottenuto l’Indicazione Geografica Protetta e sarà immessa sul mercato a partire da quest’estate con il marchio IGP.
Quali sono le particolarità che la rendono unica?
Rappresenta il forte legame che la nostra azienda ha con il territorio. Parte dal nome, Lucana Salumi, e prosegue con la tradizione e la cura che mettiamo in ogni lavorazione. È un prodotto che nasce nel rispetto dei saperi contadini e arriva oggi sulle tavole di tutti gli italiani, coniugando tradizione e innovazione tecnologica.

And what about the raw materials you use?
We use only Italian pork, never frozen. The seasoning is based on wild fennel seeds harvested by local farmers, along with black pepper and chili flakes, giving us both sweet and spicy versions.
Everything is stuffed into natural casing and made from the finest cuts, from the shoulder to the noble trimmings of ham and hindquarters.
Besides the Lucanica, how broad is your product range?
We offer a wide variety: raw ham, soppressata, rolled pancetta, capocollo, another of our flagship products, and of course the Lucanica, a seasoned sausage.
In addition, with the support of new technologies, we have set up a clean room where we also slice not only our products but other traditional Italian cured meats as well.
This allows us to cater to modern distribution channels in addition to normal trade and the Horeca sector, which has always been our main market.
So, you are addressing a diversified market
Exactly. Our strategy is to diversify, targeting all channels with specific product lines. This way, we can reach different market segments while maintaining the quality that sets us apart.
Lucana Salumi is deeply rooted in the territory but also forward-looking. How important is this balance?
It is fundamental. The company was founded in 1969 with the idea of bringing typical Lucanian products to the tables of Potenza, Naples, and Rome.
With the second generation, we are expanding our presence across all of Italy and developing an internationalization project to promote our cured meats abroad.
Per quanto riguarda le materie prime che impiegate, cosa può dirci?
Utilizziamo solo carni di suino nazionale, mai congelate. Condiamo con semi di finocchio selvatico raccolti dai contadini della nostra area, pepe e peperoncino a scaglie, così da offrire sia la versione dolce che quella piccante.
Il tutto è insaccato in budello naturale e realizzato con i tagli migliori, dalla spalla ai triti nobili di prosciutto e fondelli.
Oltre alla Lucanica, qual è l’ampiezza della vostra gamma?
Abbiamo una vasta offerta: prosciutto crudo, soppressata, pancetta tesa, capocollo, che è un altro nostro prodotto di punta, e naturalmente la lucanica, una salsiccia stagionata.
Inoltre, con le nuove tecnologie, abbiamo realizzato una camera bianca in cui effettuiamo anche l’affettamento, sia dei nostri salumi che di altri prodotti tipici italiani. Questo ci consente di rivolgerci alla distribuzione moderna oltre che al normal trade e al canale Horeca, che da sempre è il nostro riferimento.
Quindi si tratta di un mercato diversificato. Esatto. La nostra politica è proprio quella di differenziare, andando a presidiare tutte le tipologie di canali con linee specifiche di prodotto.
In questo modo riusciamo a raggiungere segmenti diversi, mantenendo la qualità che ci contraddistingue.
Lucana Salumi è molto legata al territorio, ma guarda anche avanti. Quanto conta questo equilibrio? È fondamentale. L’azienda nasce nel 1969 con l’idea di portare le produzioni tipiche lucane sulle tavole di Potenza, Napoli e Roma.
Con la seconda generazione stiamo ampliando la presenza in tutta Italia e portando avanti un progetto di internazionalizzazione per far conoscere i nostri salumi anche all’estero.
Watch the full interview


You are regular exhibitors at major trade fairs. Will we see you again at Cibus?
We already have a visit to Cibus planned, so we look forward to meeting everyone there.
Lucana Salumi thus stands as a shining example of how a family business can grow without losing its bond with the land.
From the choice of raw materials to respect for artisanal methods, combined with the introduction of technologies that ensure safety and high standards, the company has become a true ambassador of Southern Italy’s flavors.
A tradition strengthened by solid roots, now opening to the future through innovation and a strong presence in new markets, bringing the authentic taste of Basilicata ever further afield without ever losing its identity.
www.lucanasalumi.it
Siete ormai ospiti abituali delle grandi fiere. Vi rivedremo anche a Cibus?
Abbiamo già in programma una visita al Cibus, quindi contiamo di incontrarvi anche lì.
Lucana Salumi si conferma così un esempio virtuoso di come un’azienda familiare possa crescere senza perdere il legame con la propria terra.
Dalla scelta delle materie prime al rispetto dei metodi artigianali, passando per l’introduzione di tecnologie che garantiscono sicurezza e standard elevati, l’impresa lucana è oggi un ambasciatore autentico del gusto del Sud Italia.
Una tradizione che, rafforzata da solide radici, si apre al futuro attraverso la capacità di innovare e di proporsi con successo a nuovi mercati, portando i sapori della Basilicata sempre più lontano, senza mai rinunciare alla propria identità.
www.lucanasalumi.it

The dairy sector is undergoing a significant transformation driven by technological innovation and growing consumer demands.
In the Middle East, where milk and its derivatives are an essential part of the diet, the industry’s evolution is merging tradition and modernity to meet increasing demands in both volume and variety.
Products like labneh, laban, and ayran have always held a special place in the region’s dietary habits. These dairy staples, prized for their fresh taste and versatility, are now benefiting from advanced technologies that enhance quality and shelf life. For example, ultrafiltration and cold pasteurization processes preserve the organoleptic properties of these products, ensuring the authentic flavors that local consumers demand.
At the same time, the market is embracing innovative dairy products. Lactose-free milk, probiotic-enriched yo-

by our editorial team
gurts, and cheeses with optimized nutritional profiles are gaining popularity, particularly among younger generations and health-conscious consumers.
These innovations are made possible by cutting-edge solutions, such as specialized enzymes for lactose re-


duction or microfiltration techniques that achieve creamier textures and more intense flavors.
Another critical aspect of the dairy sector in the Middle East is the preservation of products in a particularly hot climate. Innovations in refrigeration and packaging systems are playing a pivotal role. Advanced packaging materials that combine sustainability and thermal insula-

tion help extend product shelf life without compromising freshness. Additionally, the adoption of more efficient refrigerated logistics solutions ensures optimal distribution, even in remote areas.
Tradition, however, remains a cornerstone for local and international producers aiming to succeed in the Middle Eastern market.
Adapting products to local tastes and preferences is essential. Many companies are collaborating with chefs and local producers to create new cheese and yogurt variations incorporating traditional flavors such as saffron, dates, or mint.
This blend of tradition and innovation is not limited to the final product but extends to production processes.
The adoption of more sustainable practices, such as reducing water consumption and utilizing renewable energy in manufacturing facilities, enhances the industry’s image in the eyes of environmentally conscious consumers.
The dairy sector in the Middle East is thus continuously evolving, capable of meeting the demands of a dynamic market through a perfect balance of tradition, innovation, and sustainability. Producers who invest in advanced technologies while respecting local cultural nuances will have the privilege of participating in this exciting growth phase.


3B SRL
I COV-142/145
Via Cuneo, 90 12011 Borgo San Dalmazzo CN - Italy
A151 SRL
69
Via Antonio Gramsci, 57 20032 Cormano - MI Italy
AGRITURISMO LE CERQUE
I COV-146/149
Strada del Convento, 58
06050 Collazzone - PG Italy
ALDINO SRL A SOCIO UNICO
82/85
Via E. Montale 21/23
37052 Casaleone - VR Italy
AZIENDA AGRICOLA GIUNTOLI I COV
Via delle Costituzione, 27 51013 Chiesina Uzzanese - PT Italy
BERGADER ITALIA SRL I COV-2-60/62
Via Monte Baldo, 14/F Loc. Calzoni
37060 Villafranca di Verona VR - Italy
BIOBOTANICALS SRL 63/65
C.da Carnevale
72029 Villa Castelli - BRI taly
BIOWAY 16/19
Via Pozzobonello, 5/9 17100 Savona taly
BIRRA CASTELLO SPA I COV-66/68
Via Meucci, 1
33058 San Giorgio di Nogaro UD - Italy
BOLOGNA FIERE SPA I COV-44/46-94/97
Viale della Fiera, 20 40127 Bologna - Italy
CANTINE LOMBARDINI SRL I COV-32/35
Via Cavour, 15 42017 Novellara - RE Italy
CONSORZIO CORALIS
78/80
Strada di Olgia Vecchia SN Palazzo Canova Centro Direzionale Milano 2 20090 Segrate - MI - Italy
DEL MONTE ITALY SRL I COV
Centro Direzionale Milanofiori Strada 1, Palazzo F4 20057 Assago - MI Italy
ELOGIA MEDIA, S.L.
74/77
Rúa do Areal 18 - 3º Oficina 5 (Edificio Areal) 36201
Vigo - Spain
EPTA NORD SRL I COV
Via Padova, 58 35026 Conselve - PD - Italy
EUROPEAN SNACKS ASSOCIATION ASBL 160/163
Rue des Deux Eglises 26 1000 Brussels Belgium
FIORENTINI FIRENZE SPA
53/59
Località Belvedere 26/26A
53034 Colle di Val d’Elsa - SI Italy
FONGO SRL
I COV-114/116
Via Case Sparse Piana, 17 14030 Rocchetta Tanaro AT - Italy
FORGRANA CORRADINI SPA
86/89
Via 200 Biolche, 6 42016 Guastalla - RE - Italy
FRECCIANERA
FRATELLI BERLUCCHI
36/39
Via Broletto 2, 25040 Corte Franca - BS Italy
HOTEL RESORT IL CONVENTO RISTORANTE MASSIMO I COV-152/155
Via Hermada 3A 13039 Trino - VC - Italy
KOELNMESSE GMBH 3-6/9
Messeplatz, 1 50679 Koeln Germany
LABORATORIO
ALIMENTARE CECCHIN ANDREA E CARLO SRL
I COV-70/73
Via Maglio, 23
35015 Galliera Veneta - PD Italy
MANFREDI ALDO & C. SRL
AZIENDA VINICOLA
28/31
Via Torino, 15 12060 Farigliano - CN - Italy
MANIFATTURA PORCELLANE SARONNO SRL
81
Via Varese 2/H
21047 Saronno - VA
Italy
MANIVA SPA 90/93
Via Mignano, 15 25072 Bagolino - BS
Italy
MASIELLO FOOD SRL
I COV-98/101
Via E. De Nicola SN 71042 Cerignola - FG
Italy
MEDI SRL 10/13
Contrada Piane Tronto, 52 64010 Controguerra - TE
Italy
MEDSOL SRL
I COV-47/49
Viale A.Olivetti, 37 Zona A.S.I.
70056 Molfetta - BA
Italy
MOLINI AMBROSIO | M.A.D. SRL
I COV-156/159
Traversa Varo, 2 80053 Castellammare di Stabia NA - Italy
MOLINO BERTOLO SRL 106/109
Via Dogana Vecchia, n. 10 31040 Covolo di Pederobba TV - Italy
OLEARIA DESANTIS SPA
I COV-110/113
S.P. 231 km. 75,060 70032 Bitonto - BA - Italy
PASTA FRESCA MORENA 50/52
Via Aprosio, 21/C 18039 Ventimiglia - IM
Italy
PASTIFICIO ARTUSI SRL 24/27
Via dell’Artigianato, 60 35020 Casalserugo - PD
Italy
PIO DEL PRETE SRl I COV
Strada Consortile Zona ASI
81032 Carinaro - CE
Italy
PIUMA D’ORO SRL
117/121
Via Montesanto, 6 24047 Treviglio - BG
Italy
S.P. SPA
I COV-122/125
S.S. 31bis Vercelli-Casale 13010 Stroppiana - VC Italy
SALUMIFICIO DELLA LUCANIA SRL 164/167
Via Antonio Gramsci, 127 85055 Picerno - PZ
Italy
SALUMIFICIO NERINO MEZZALUNA SNC 126/129
Via Contrada San Girolamo, 3 63900 Fermo Italy
SATURNO SRL
I COV-130/133
Via per Caravate, 1 21036 Gemonio - VA - Italy
SOCIETA AGRICOLA COLVENDRÀ S.S. I COV-40/43
Via Liberazione, 39 (Loc. Drio Col) 31020 Refrontolo - TV Italy
TENTAZIONI PUGLIESI SRL I COV-1-134/137
SP Per Andria KM 2,00 76125 Trani - BT
Italy
WELL ALIMENTARE ITALIANA SRL 20/23
Vicolo Cristoforo Colombo, 43 31032 Casale sul Sile - TV Italy






www.editricezeus.com
www.allfoodonline.com • www.horeca-online.com